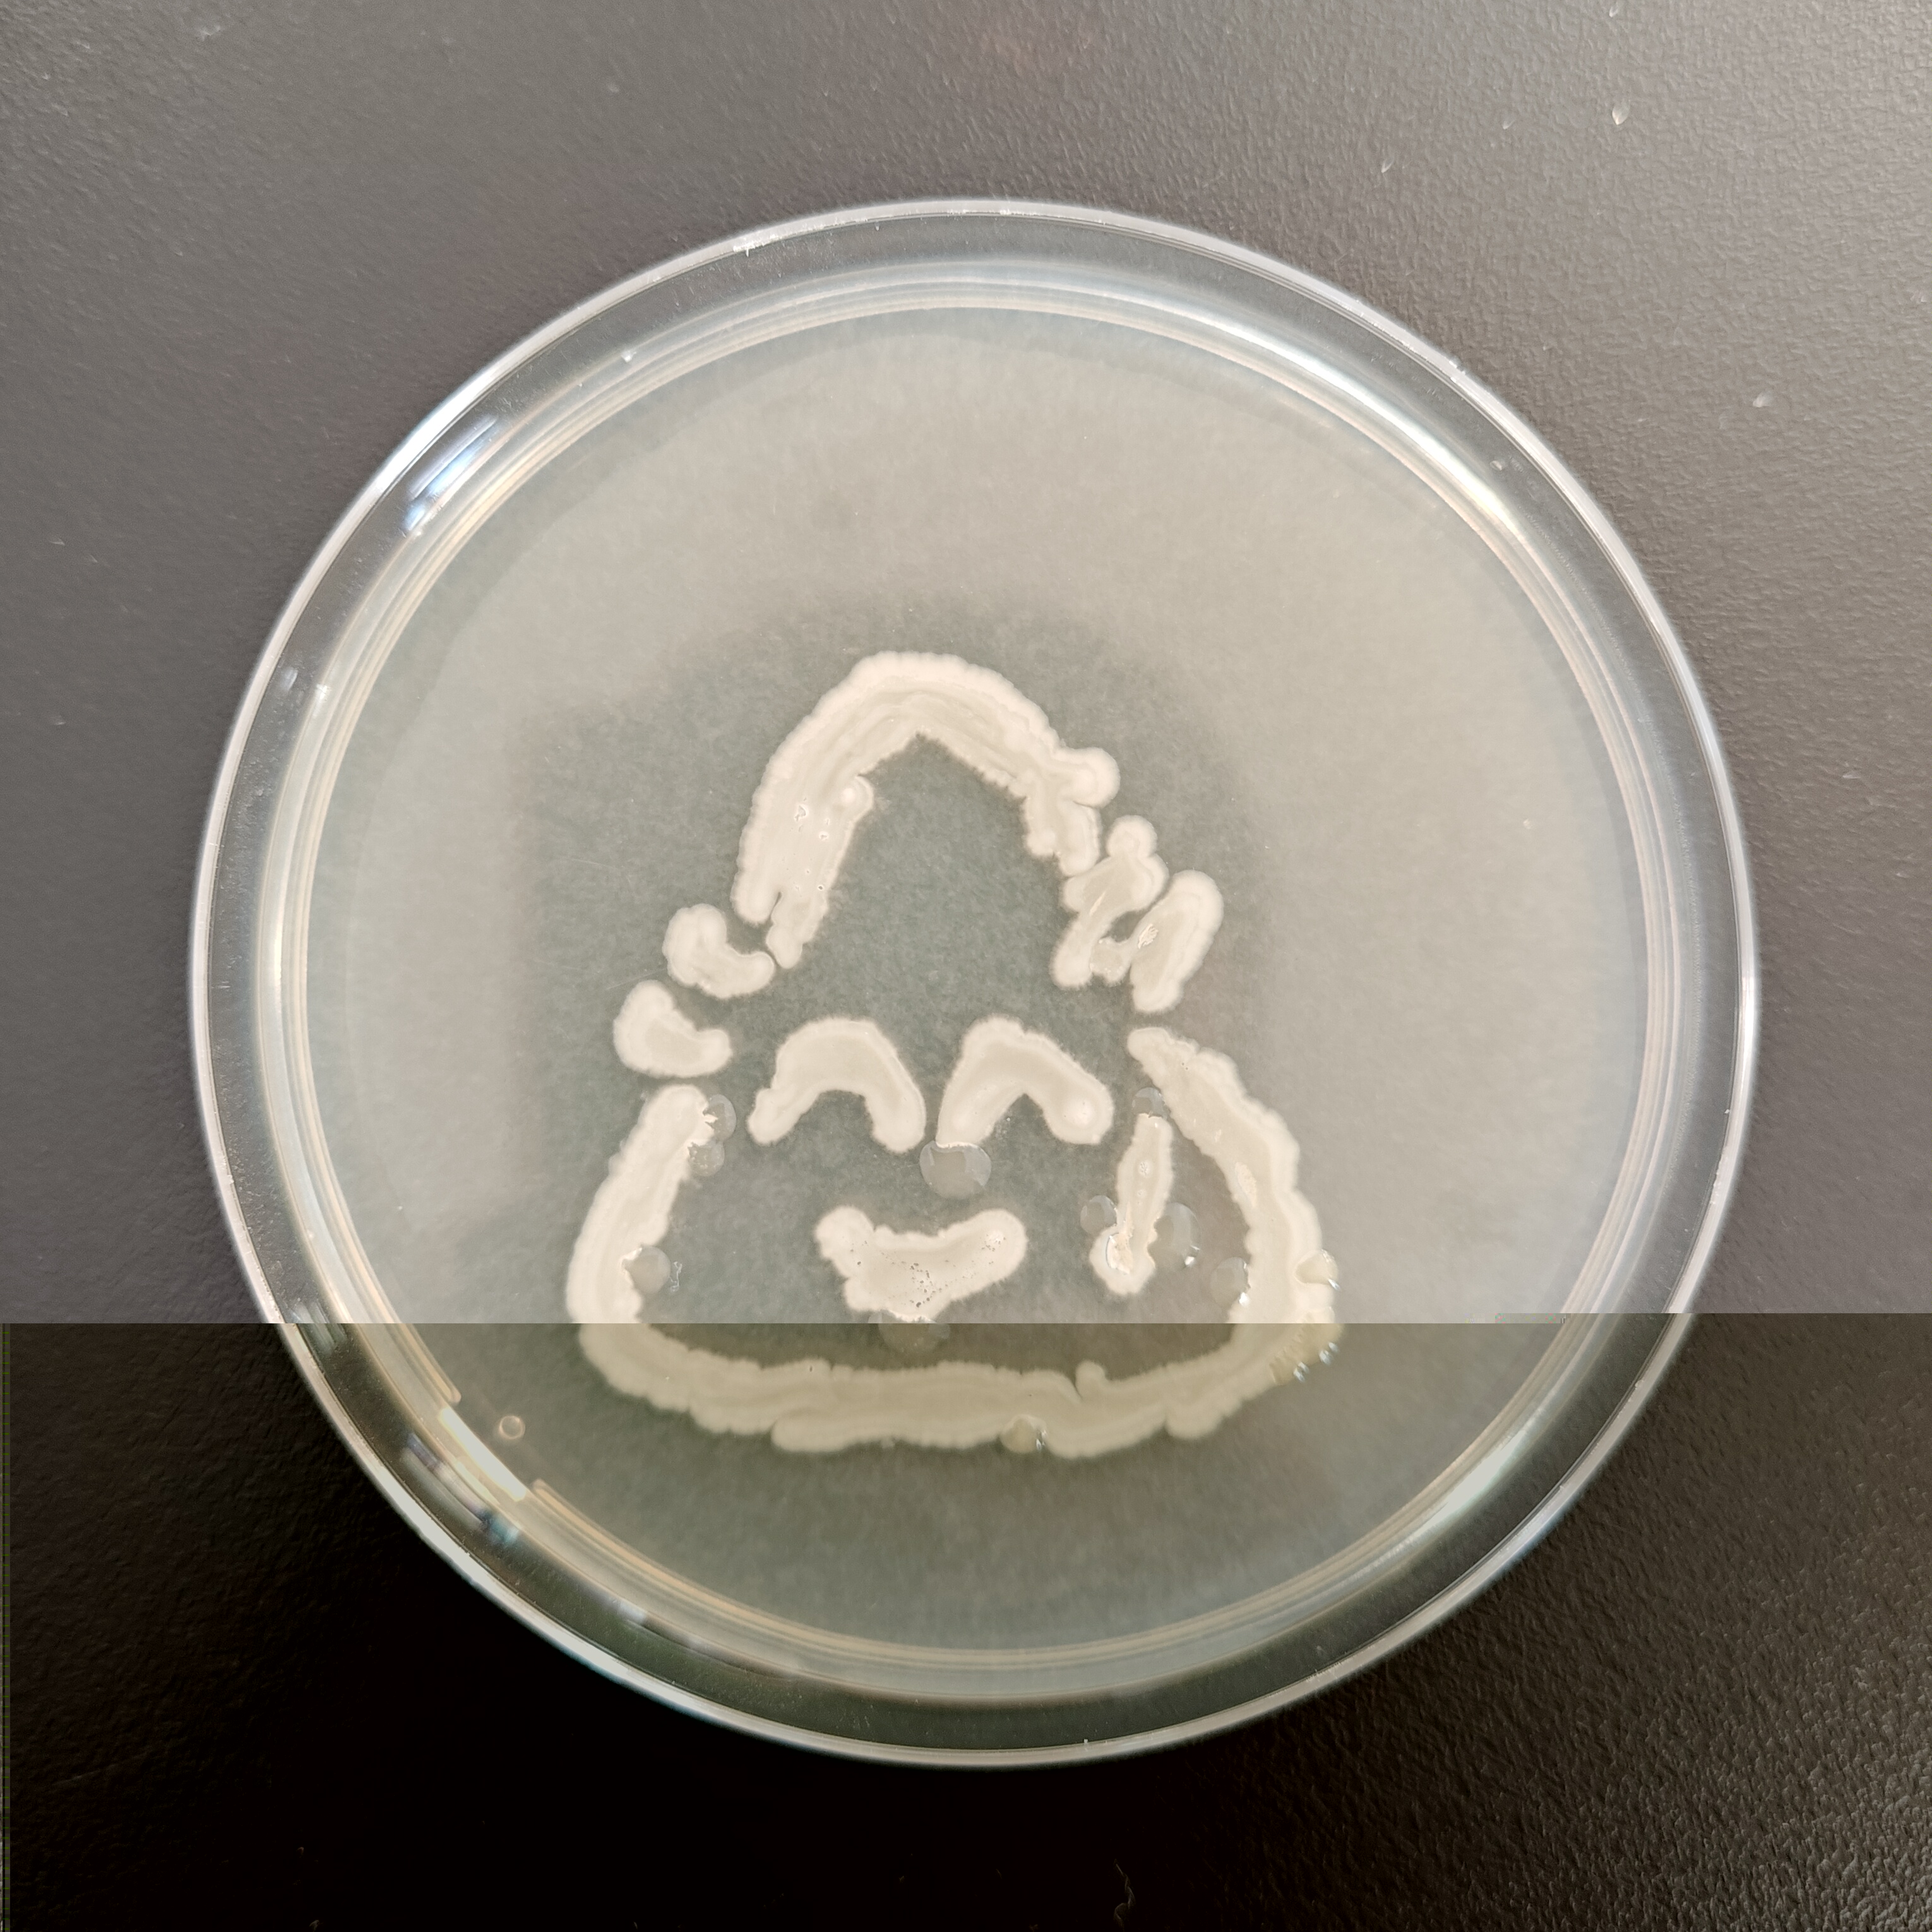
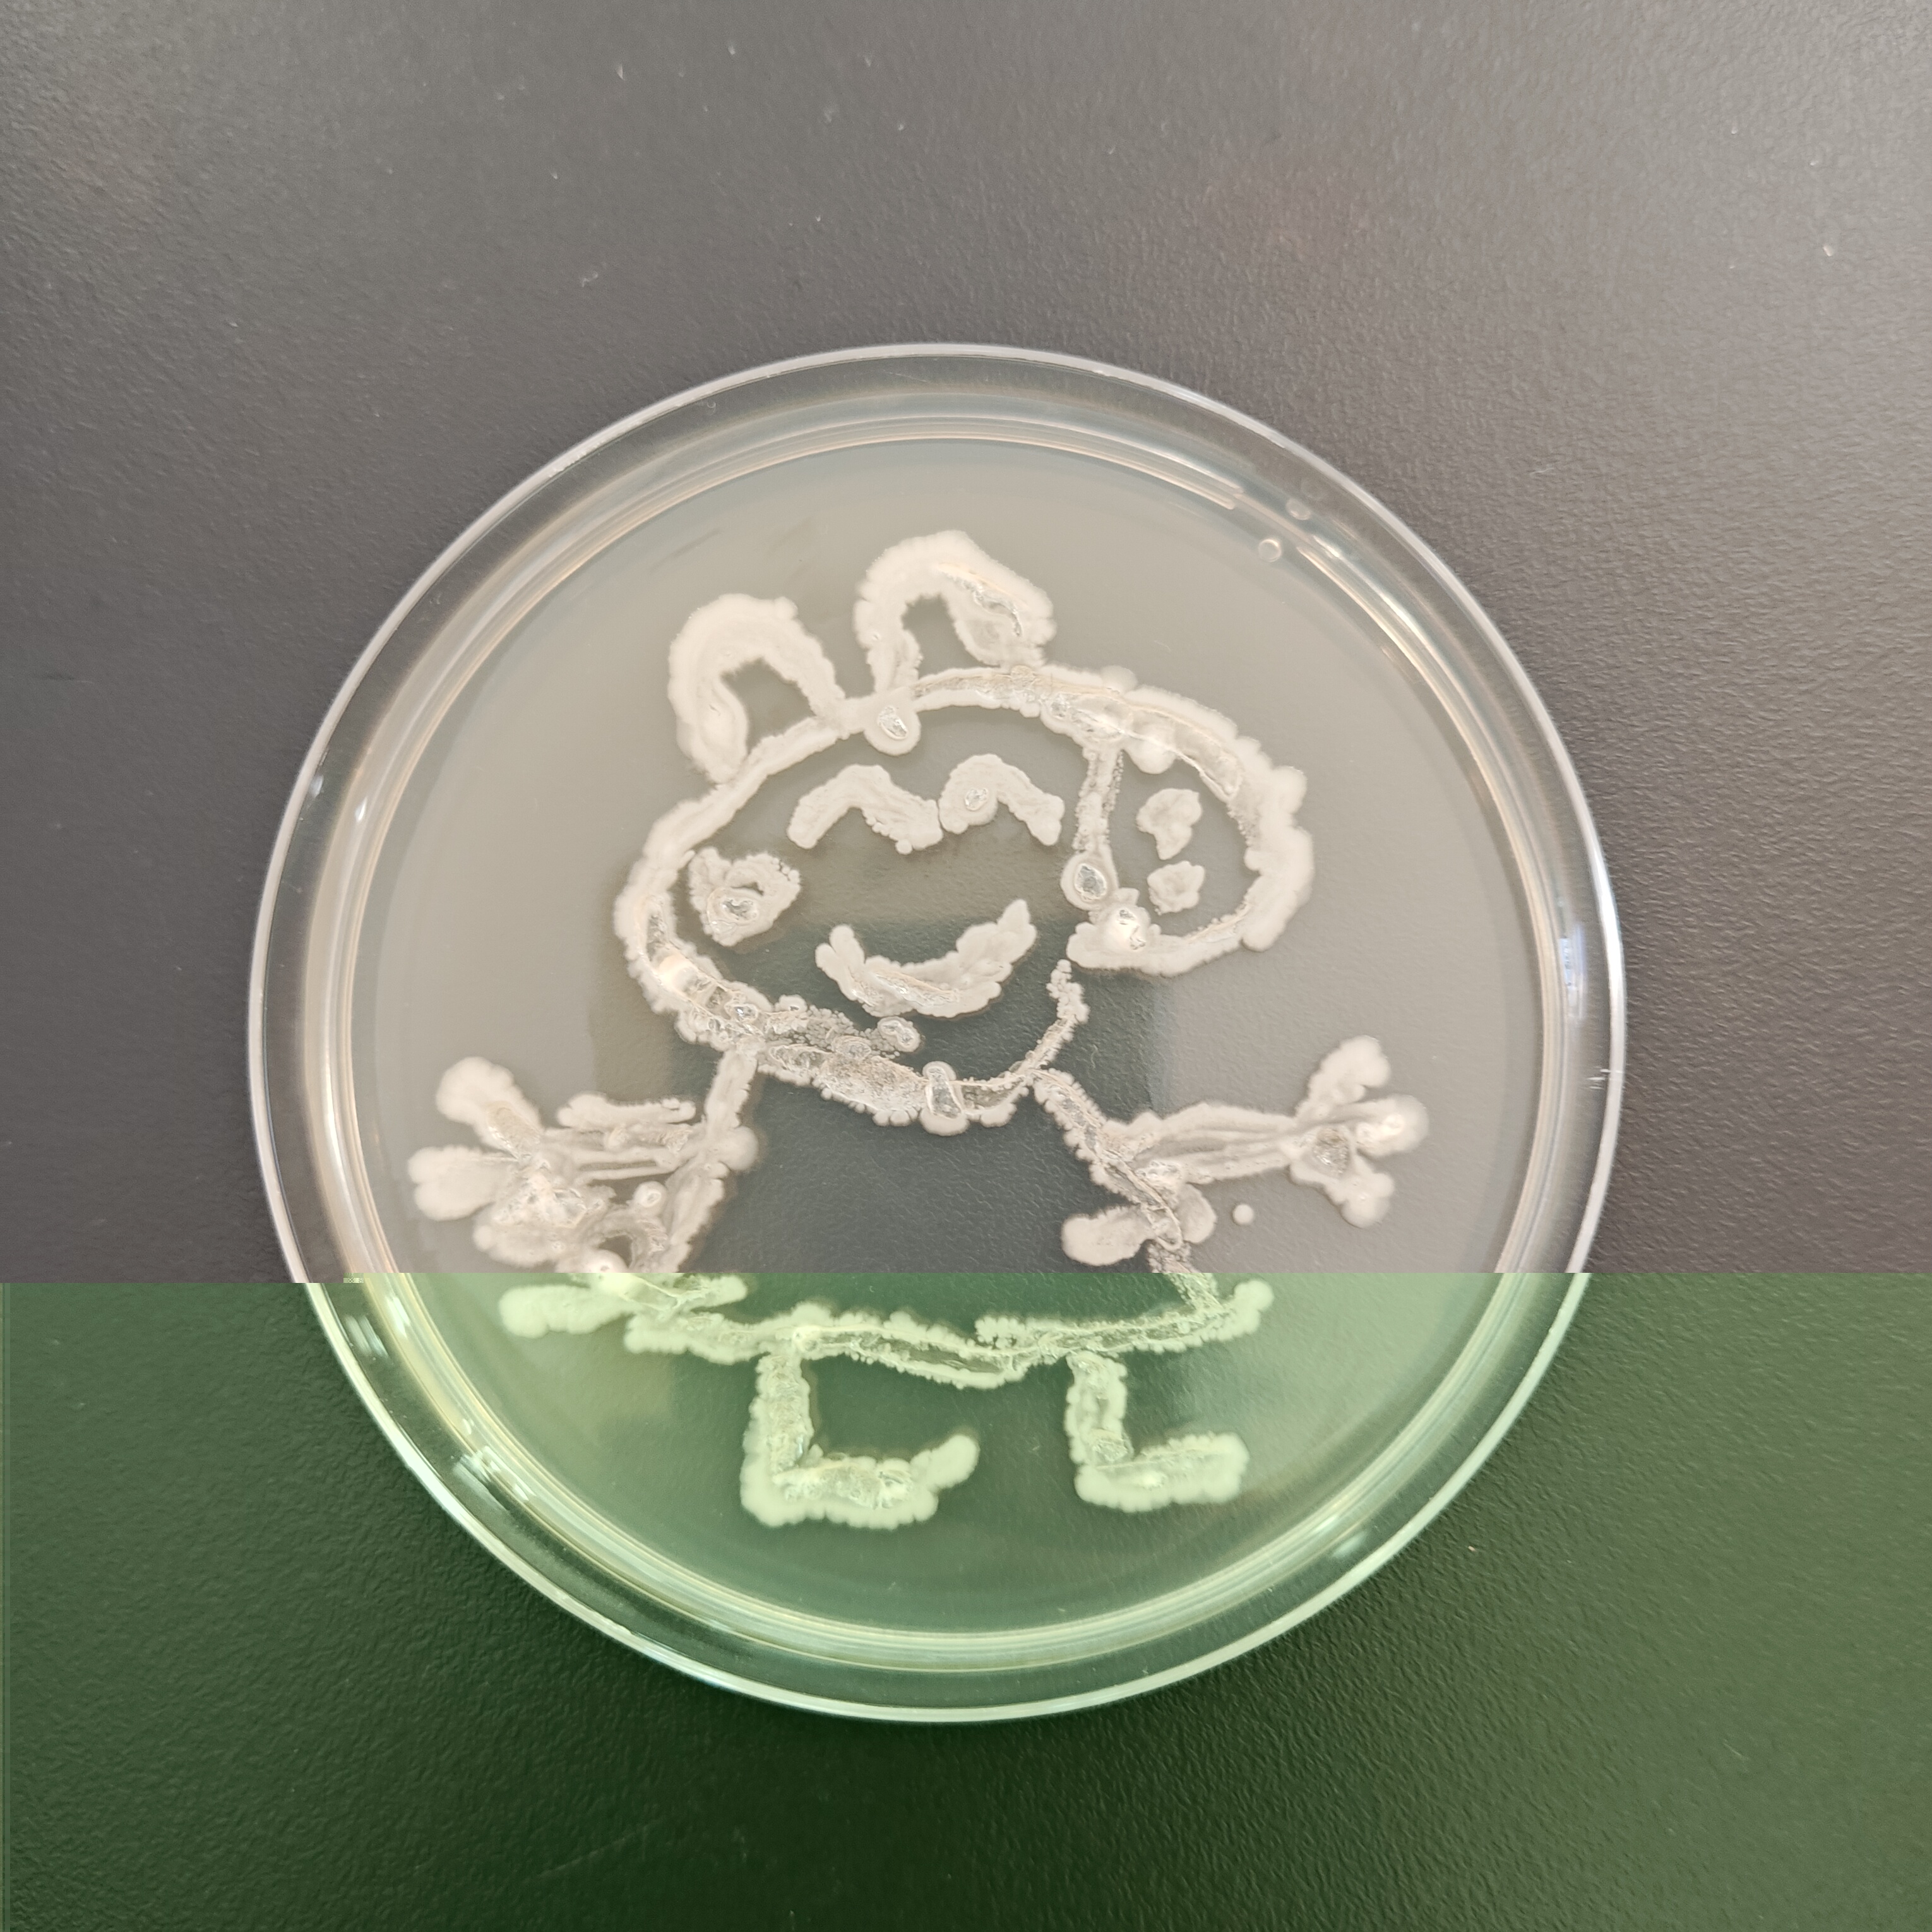
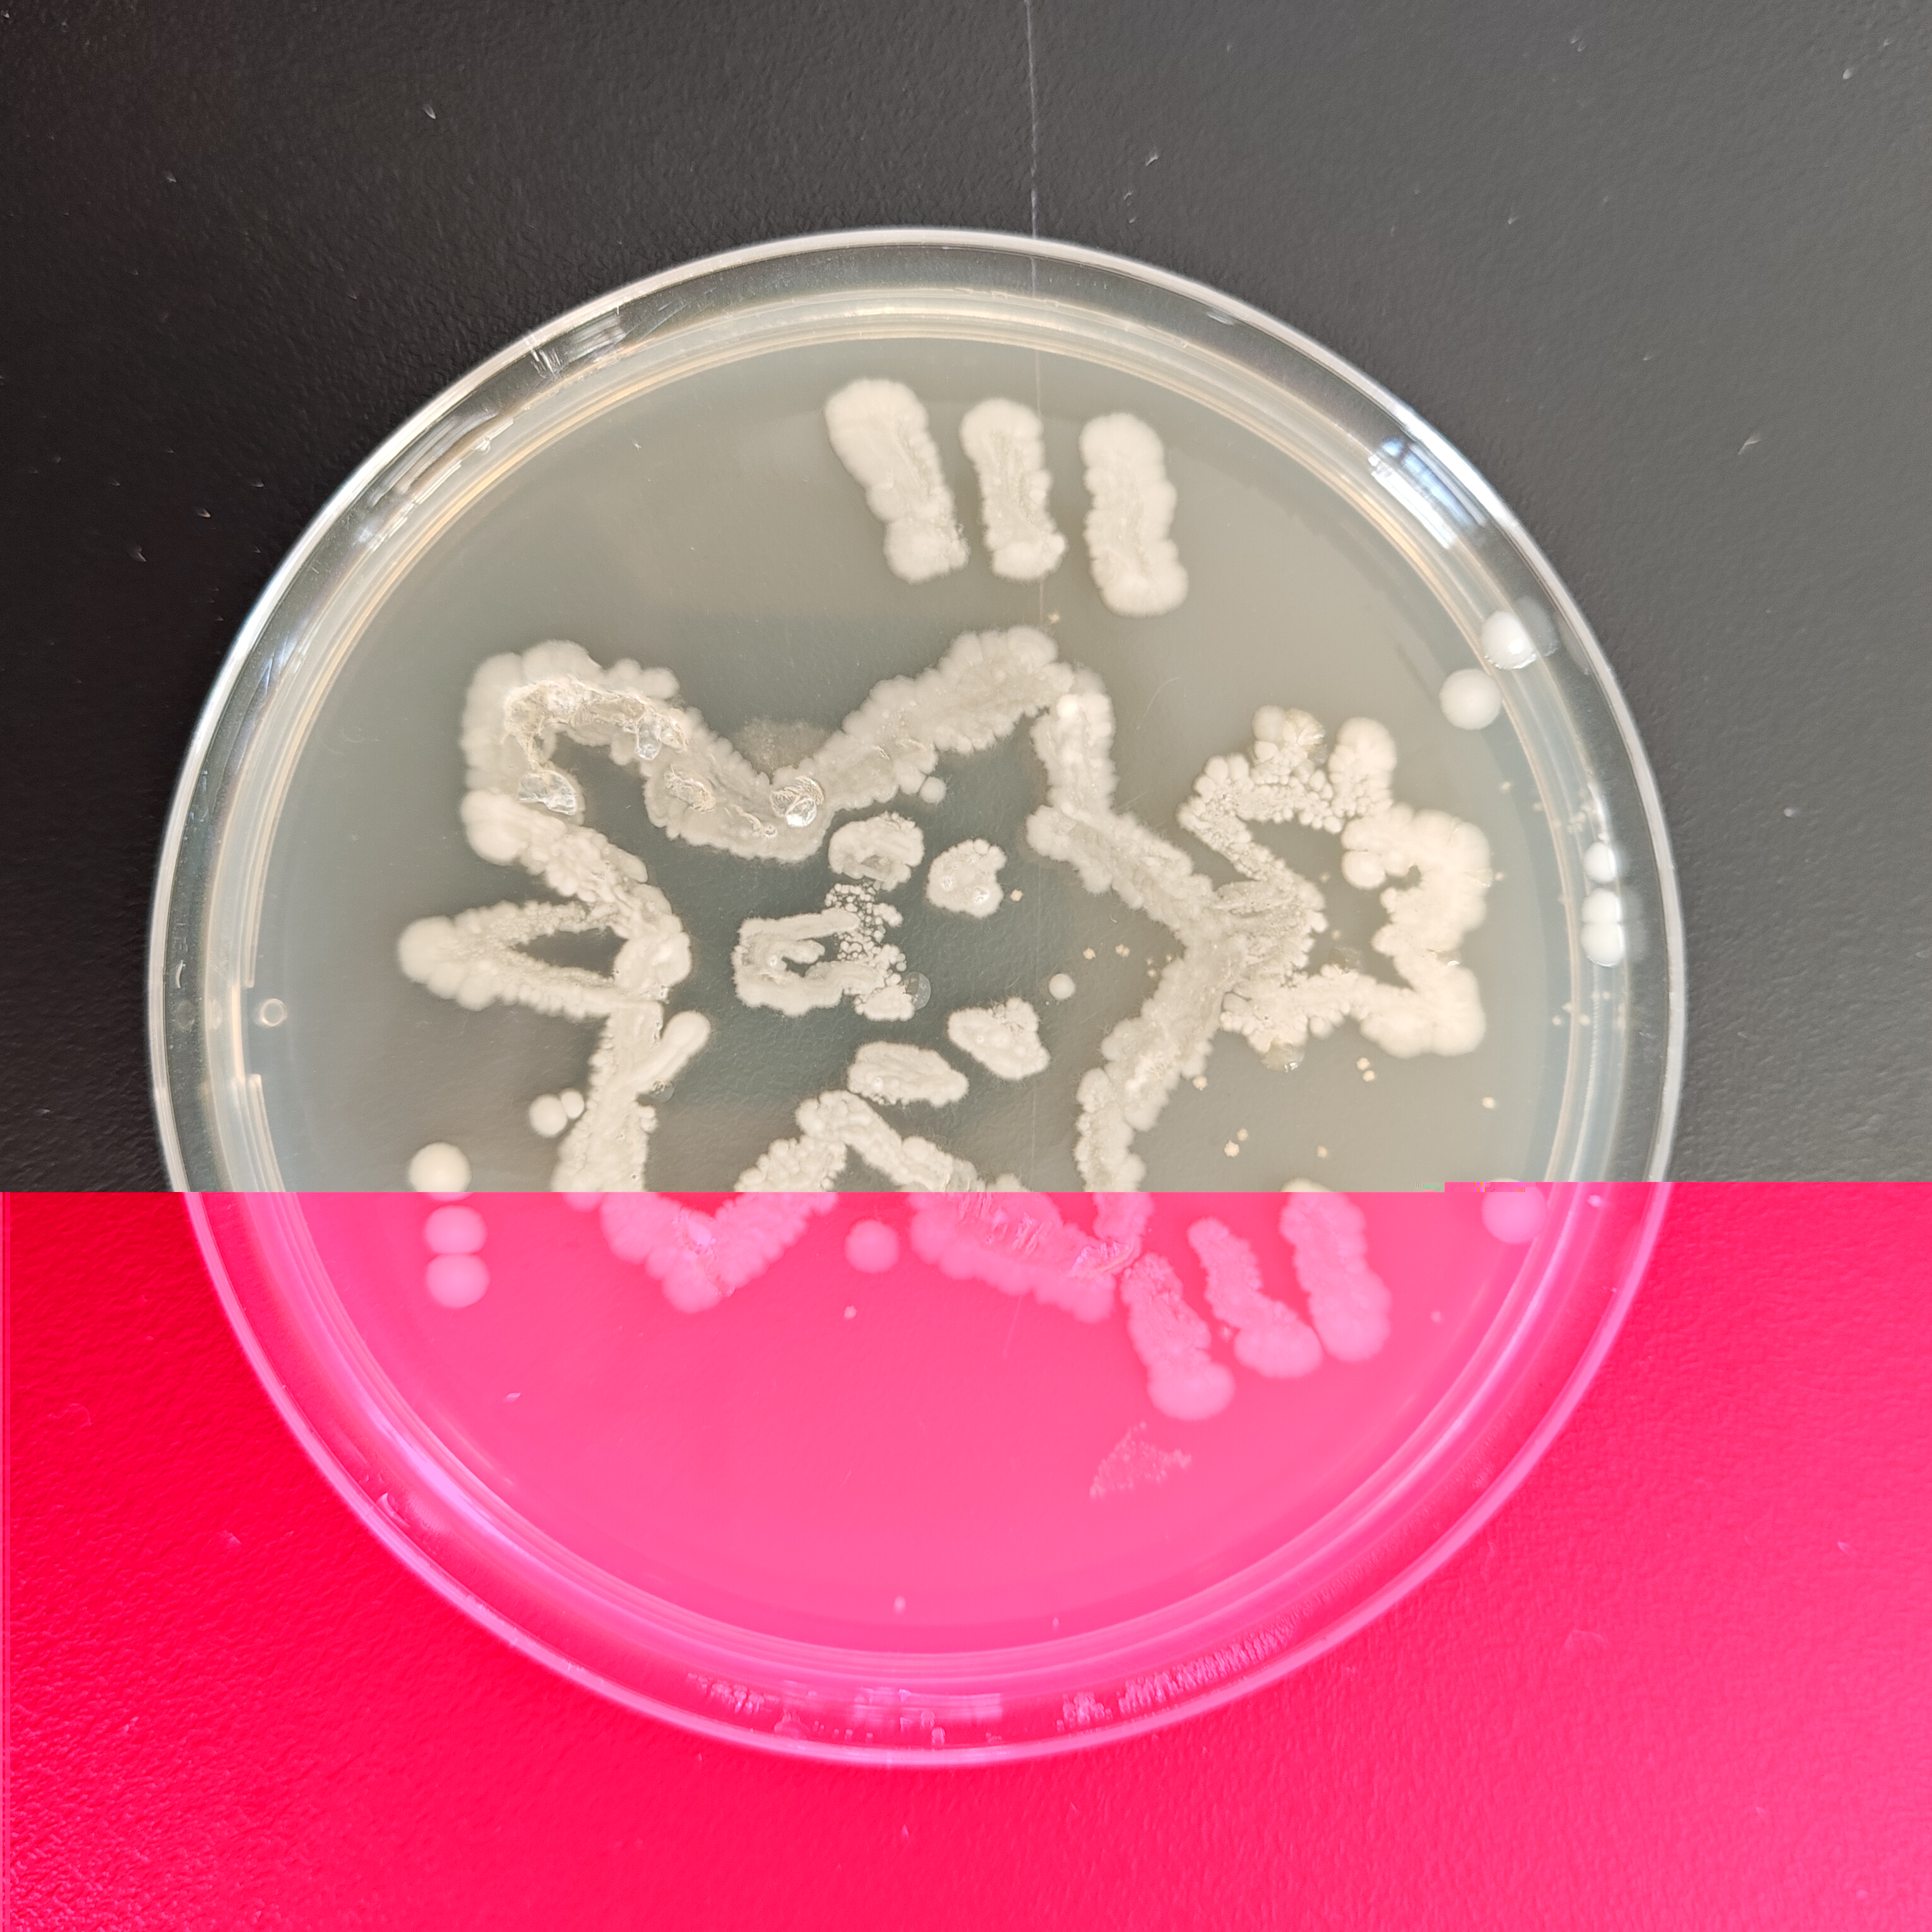
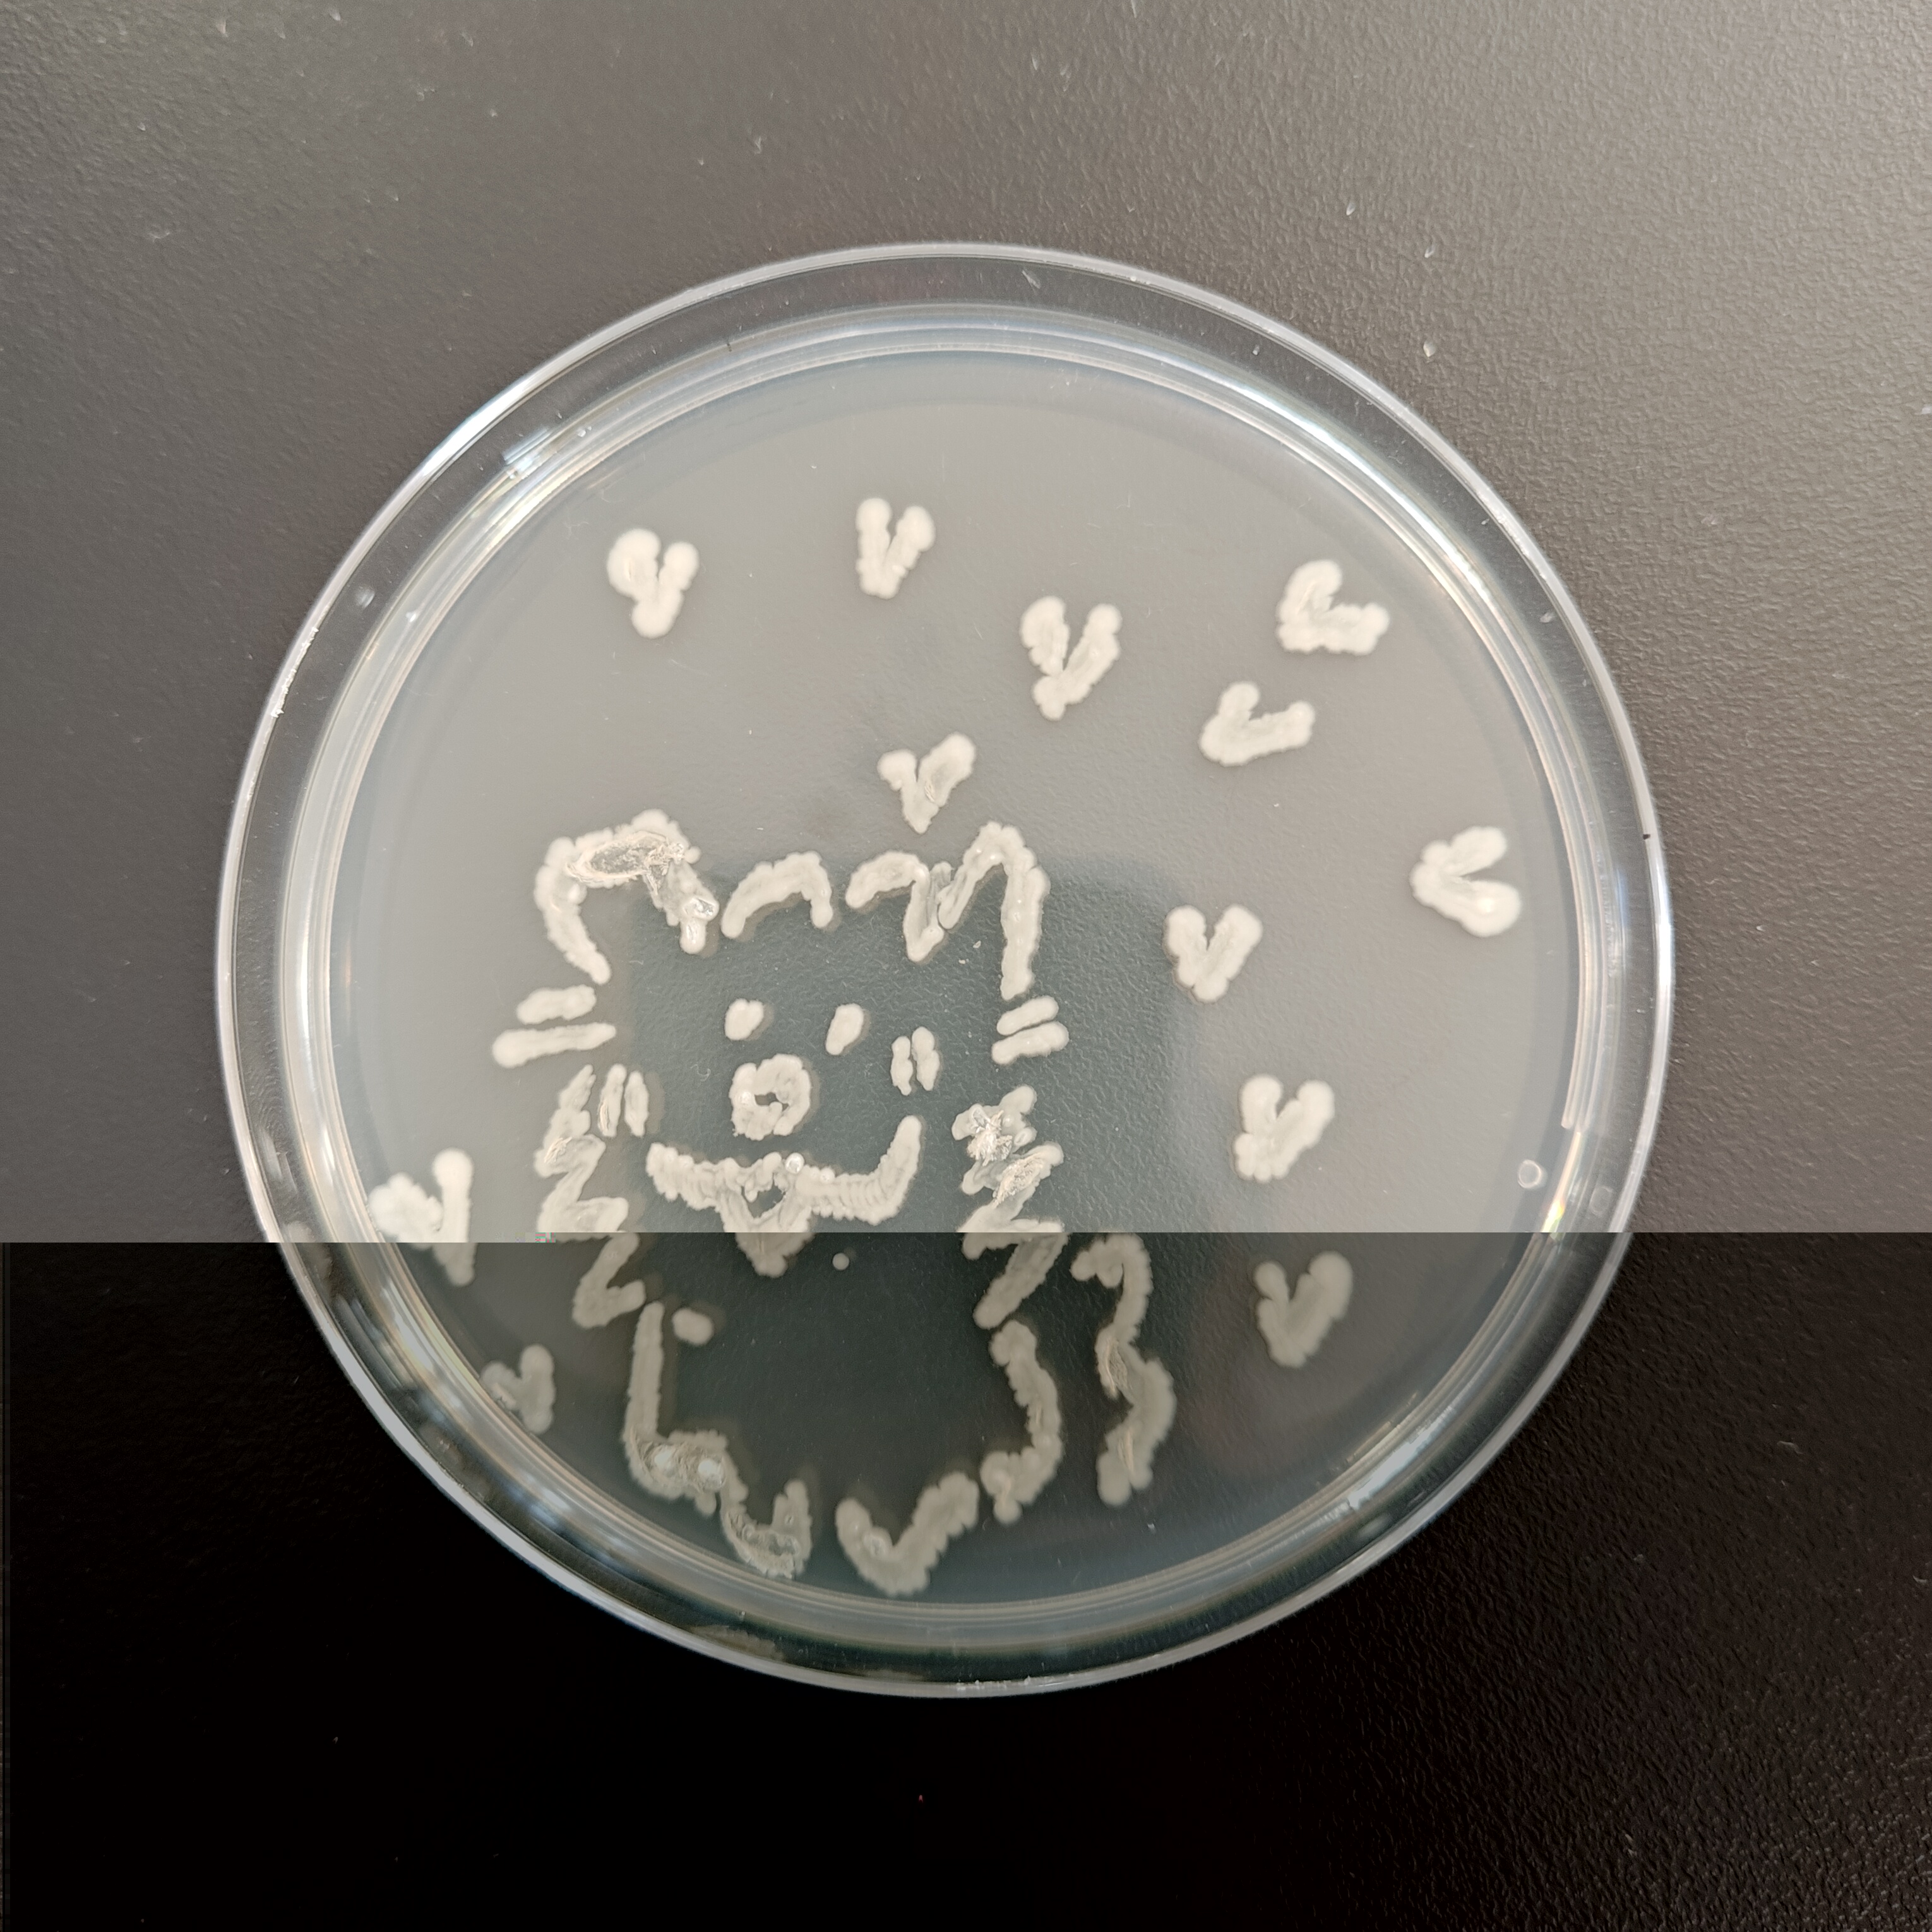
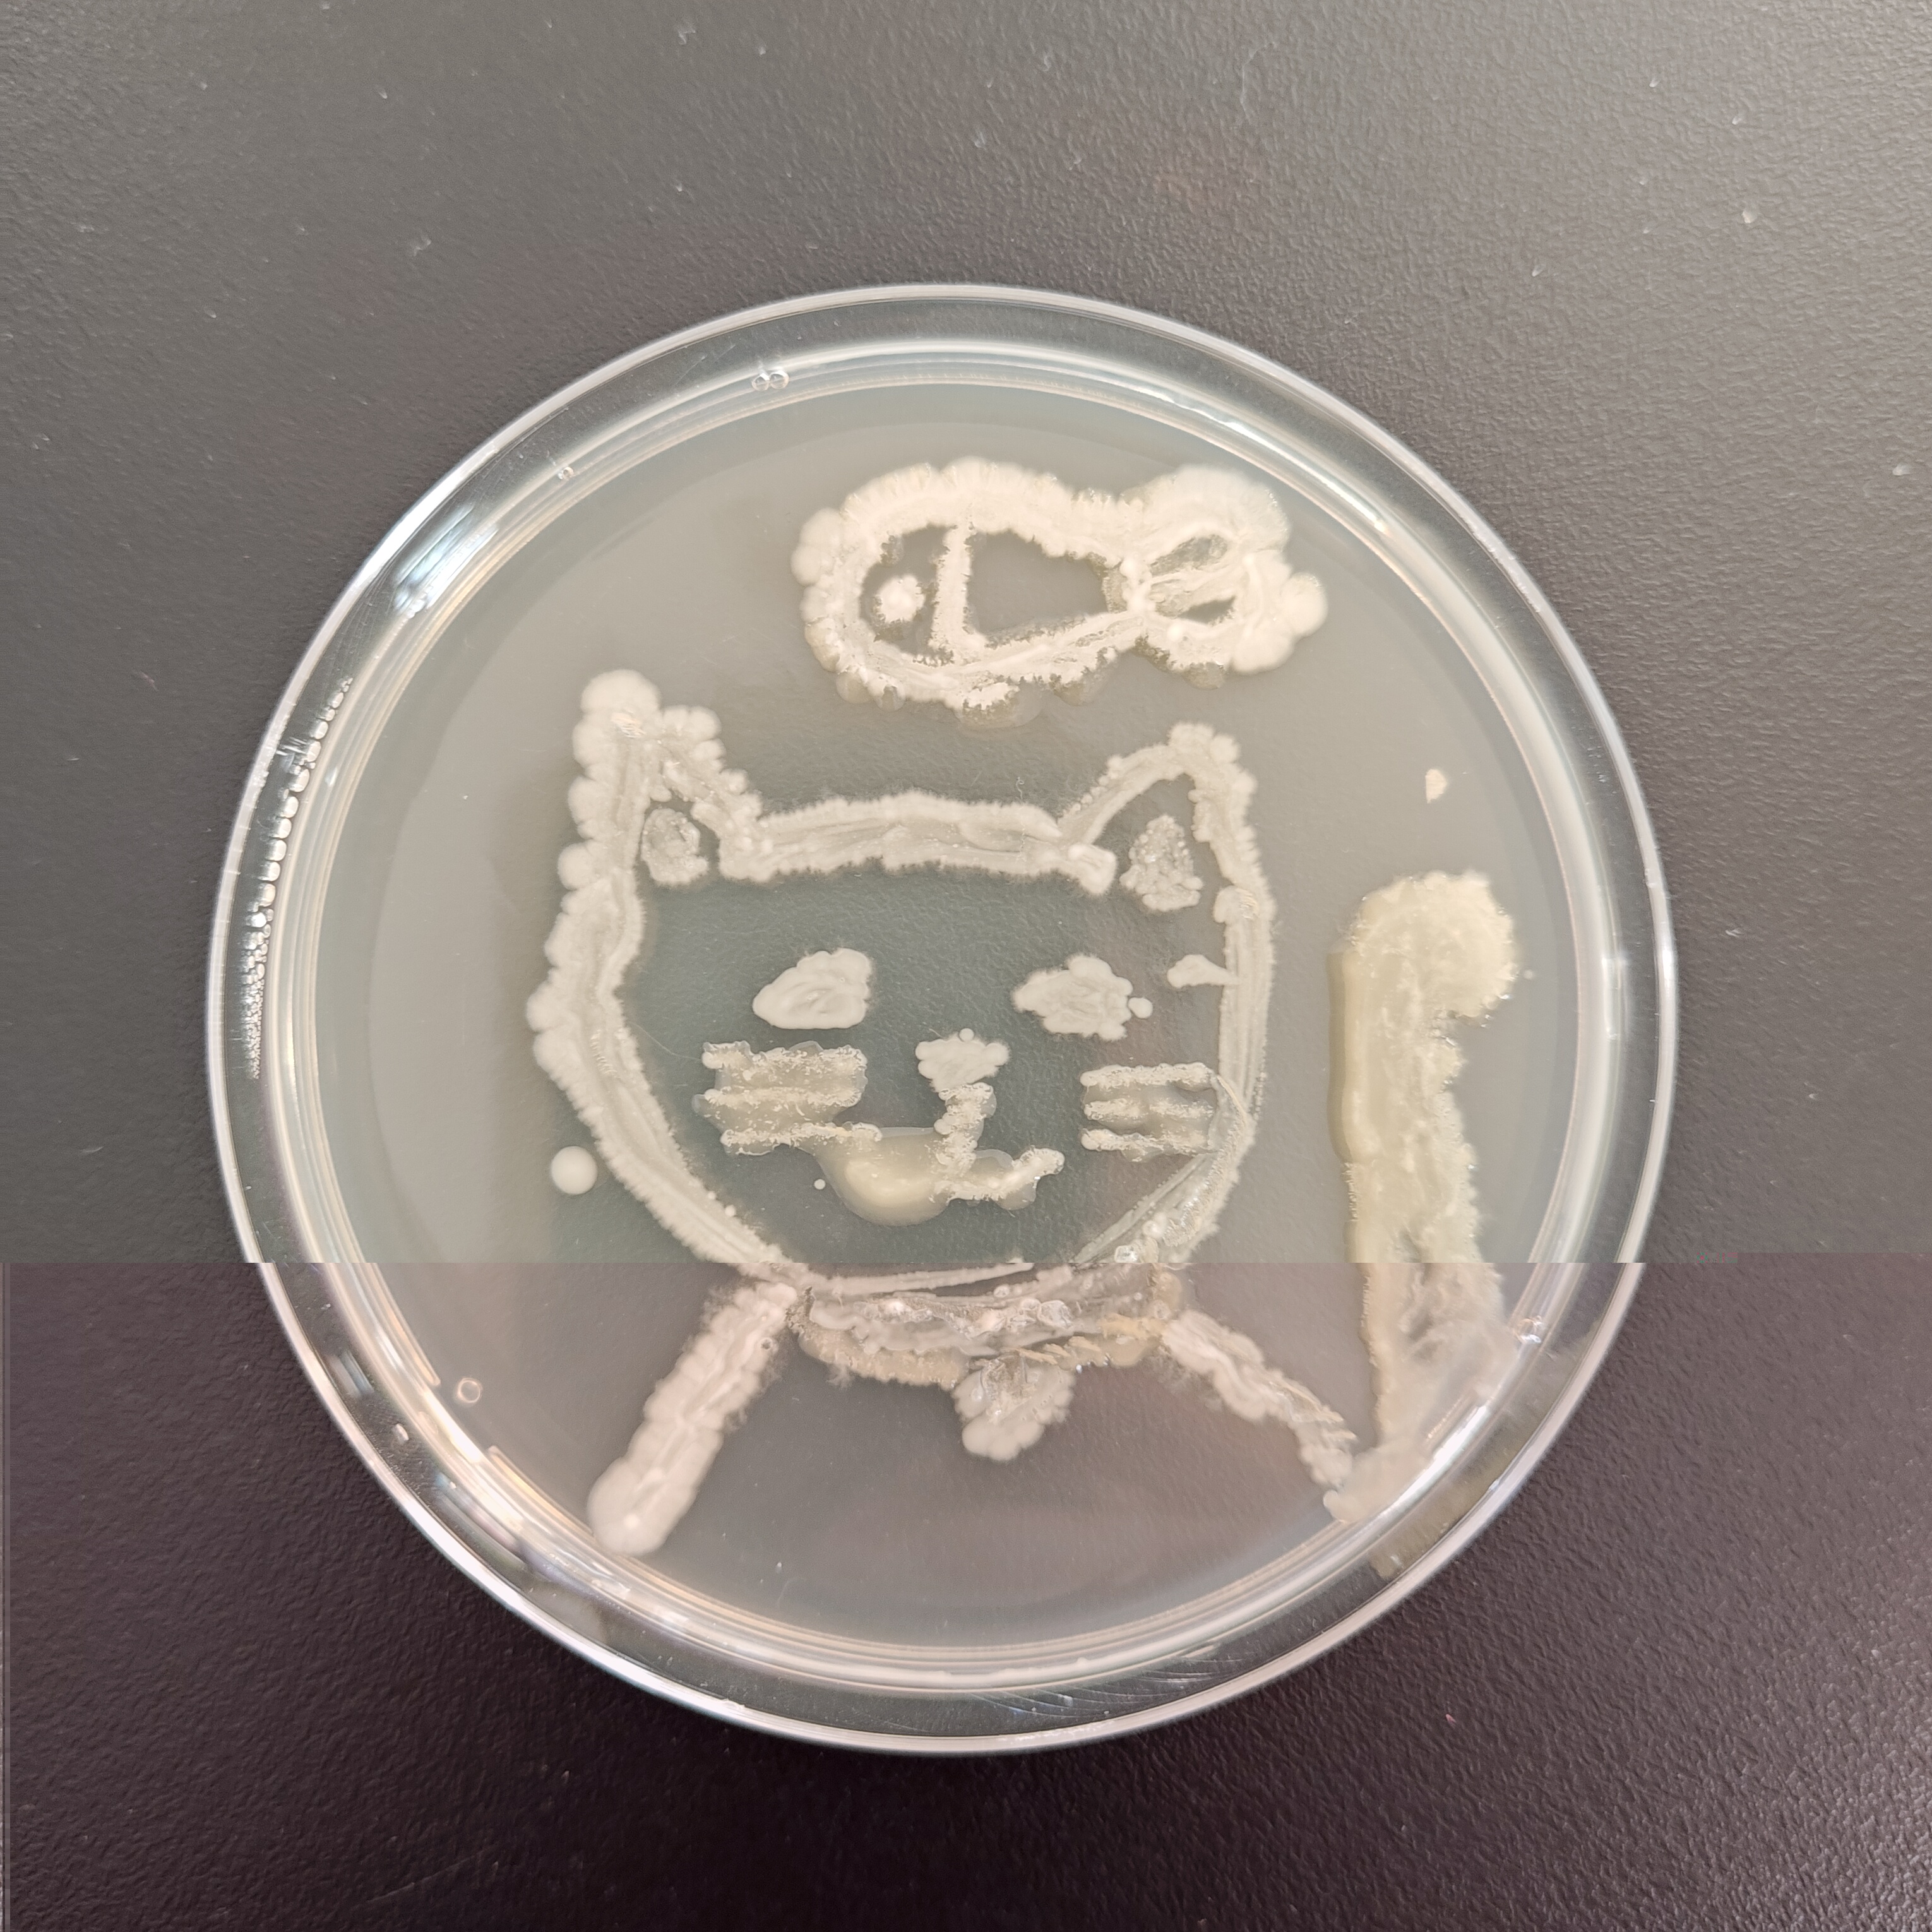
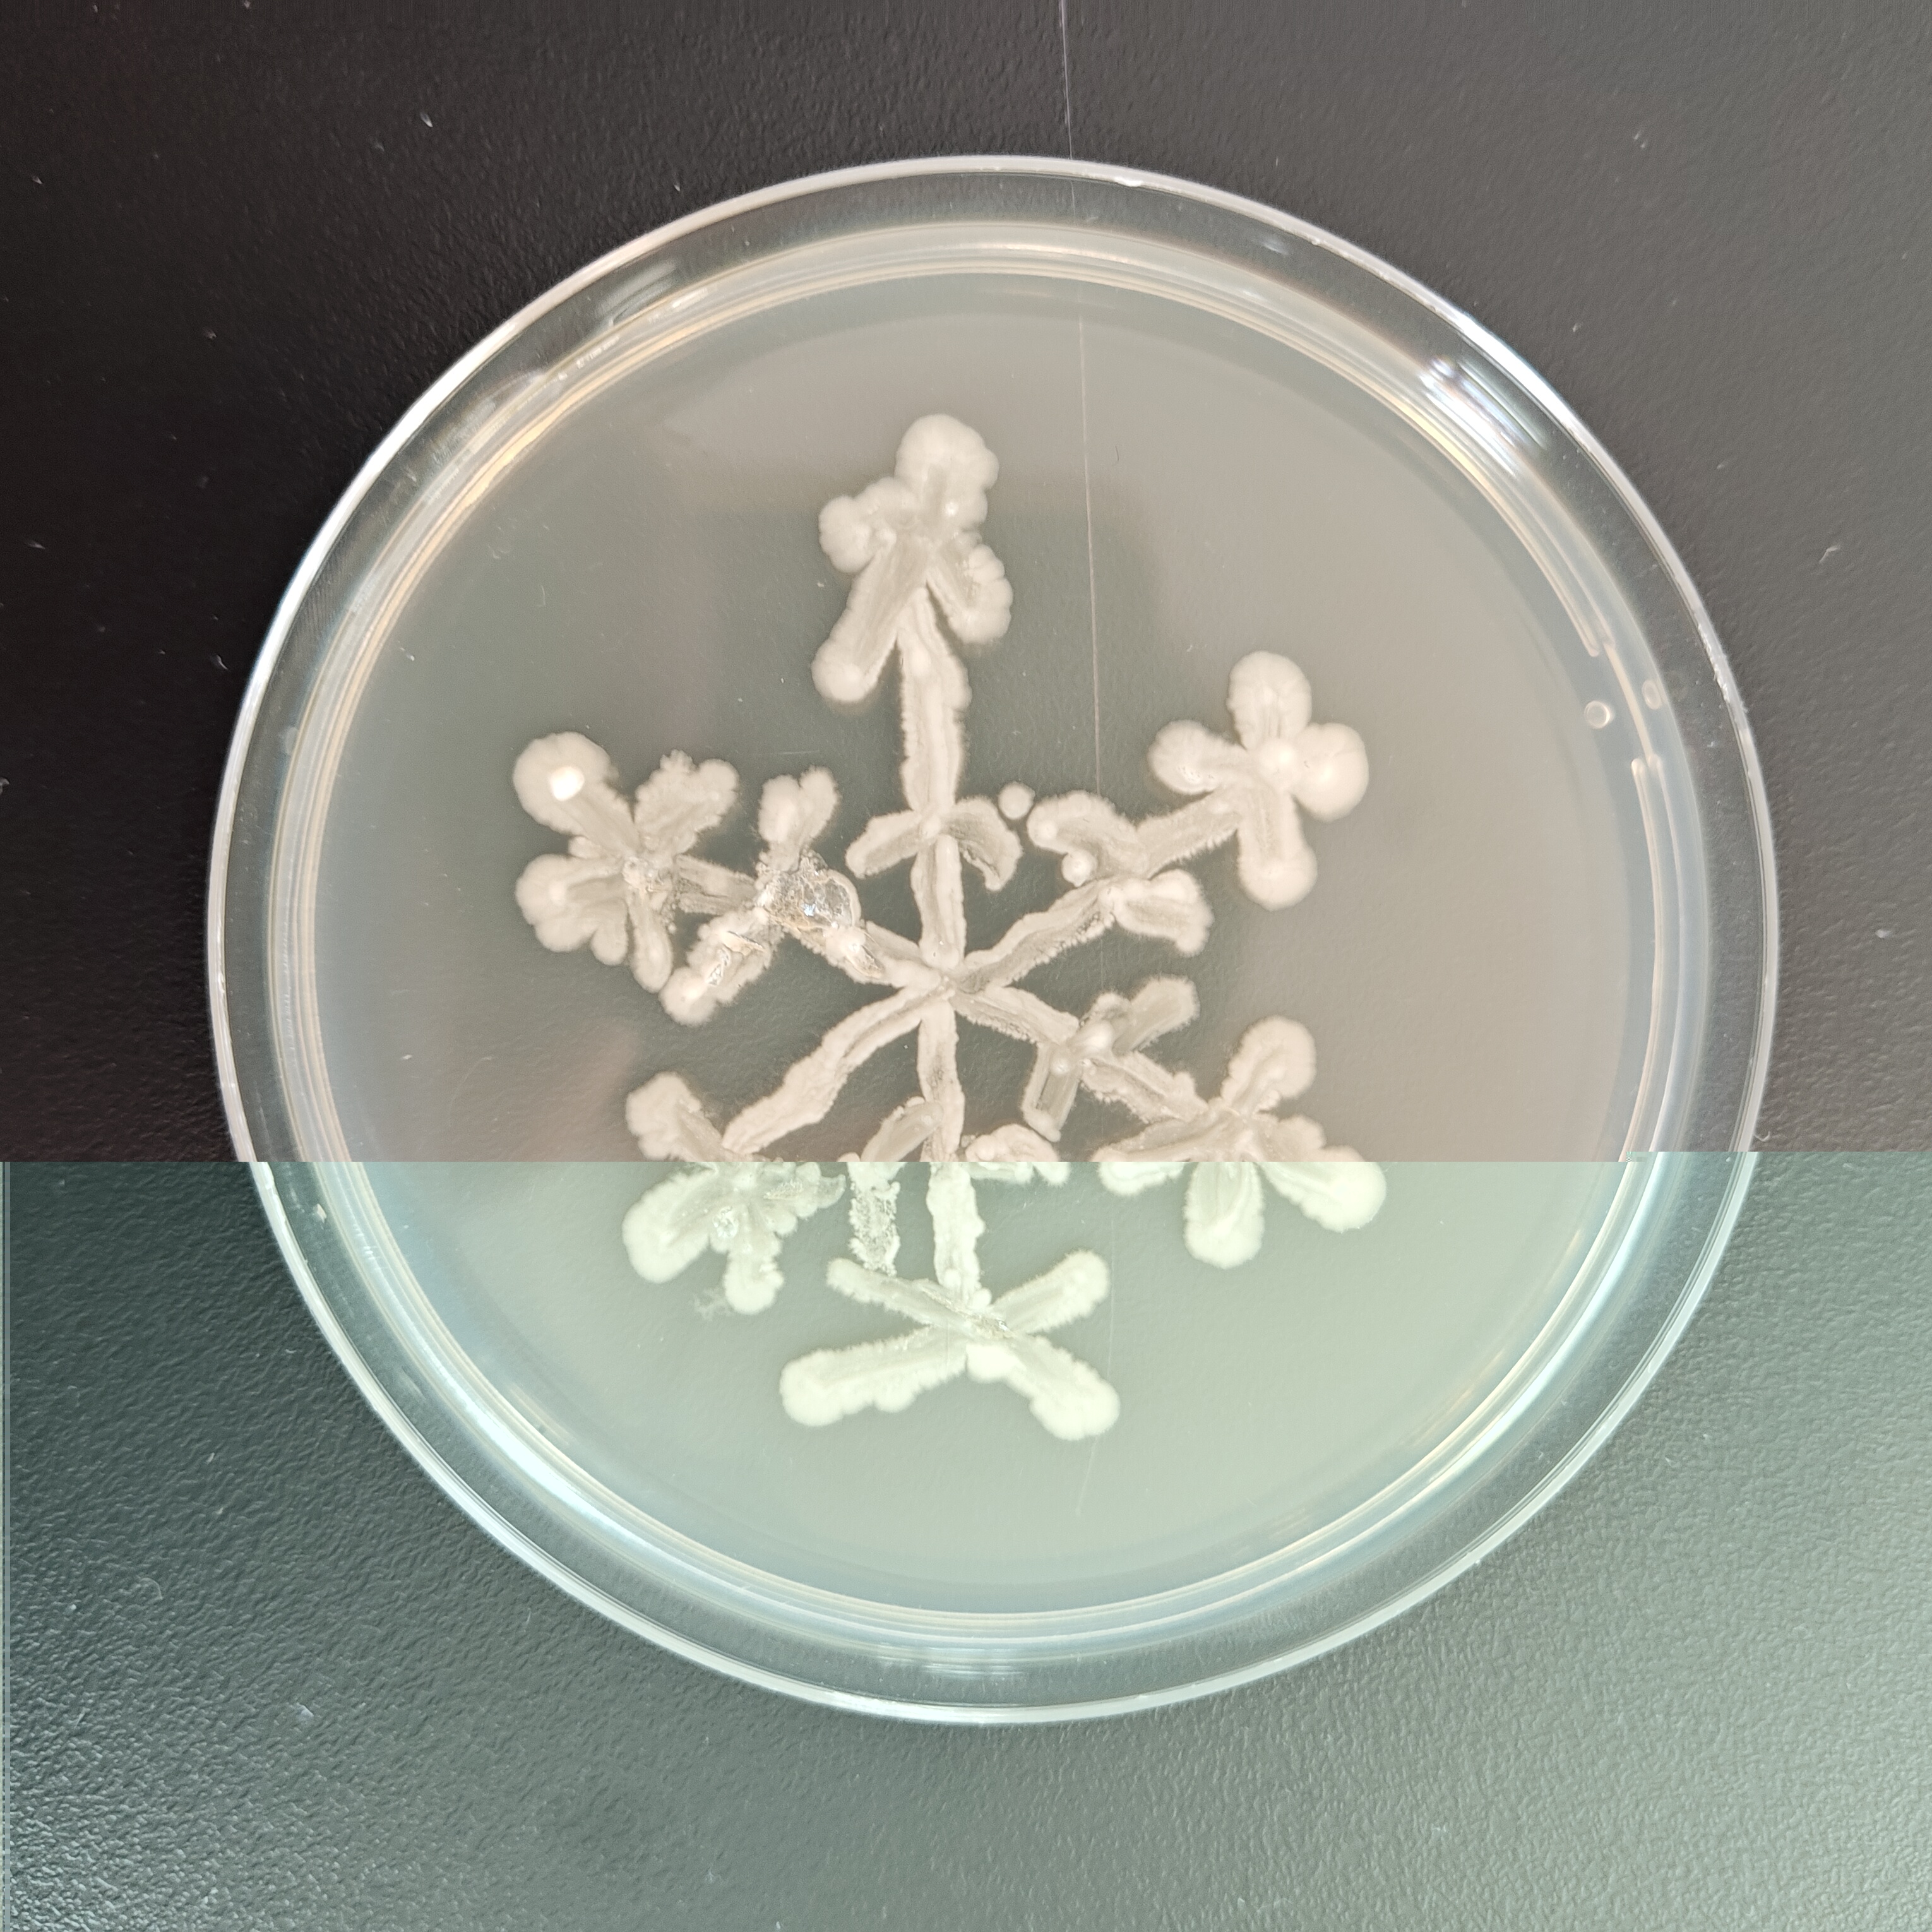
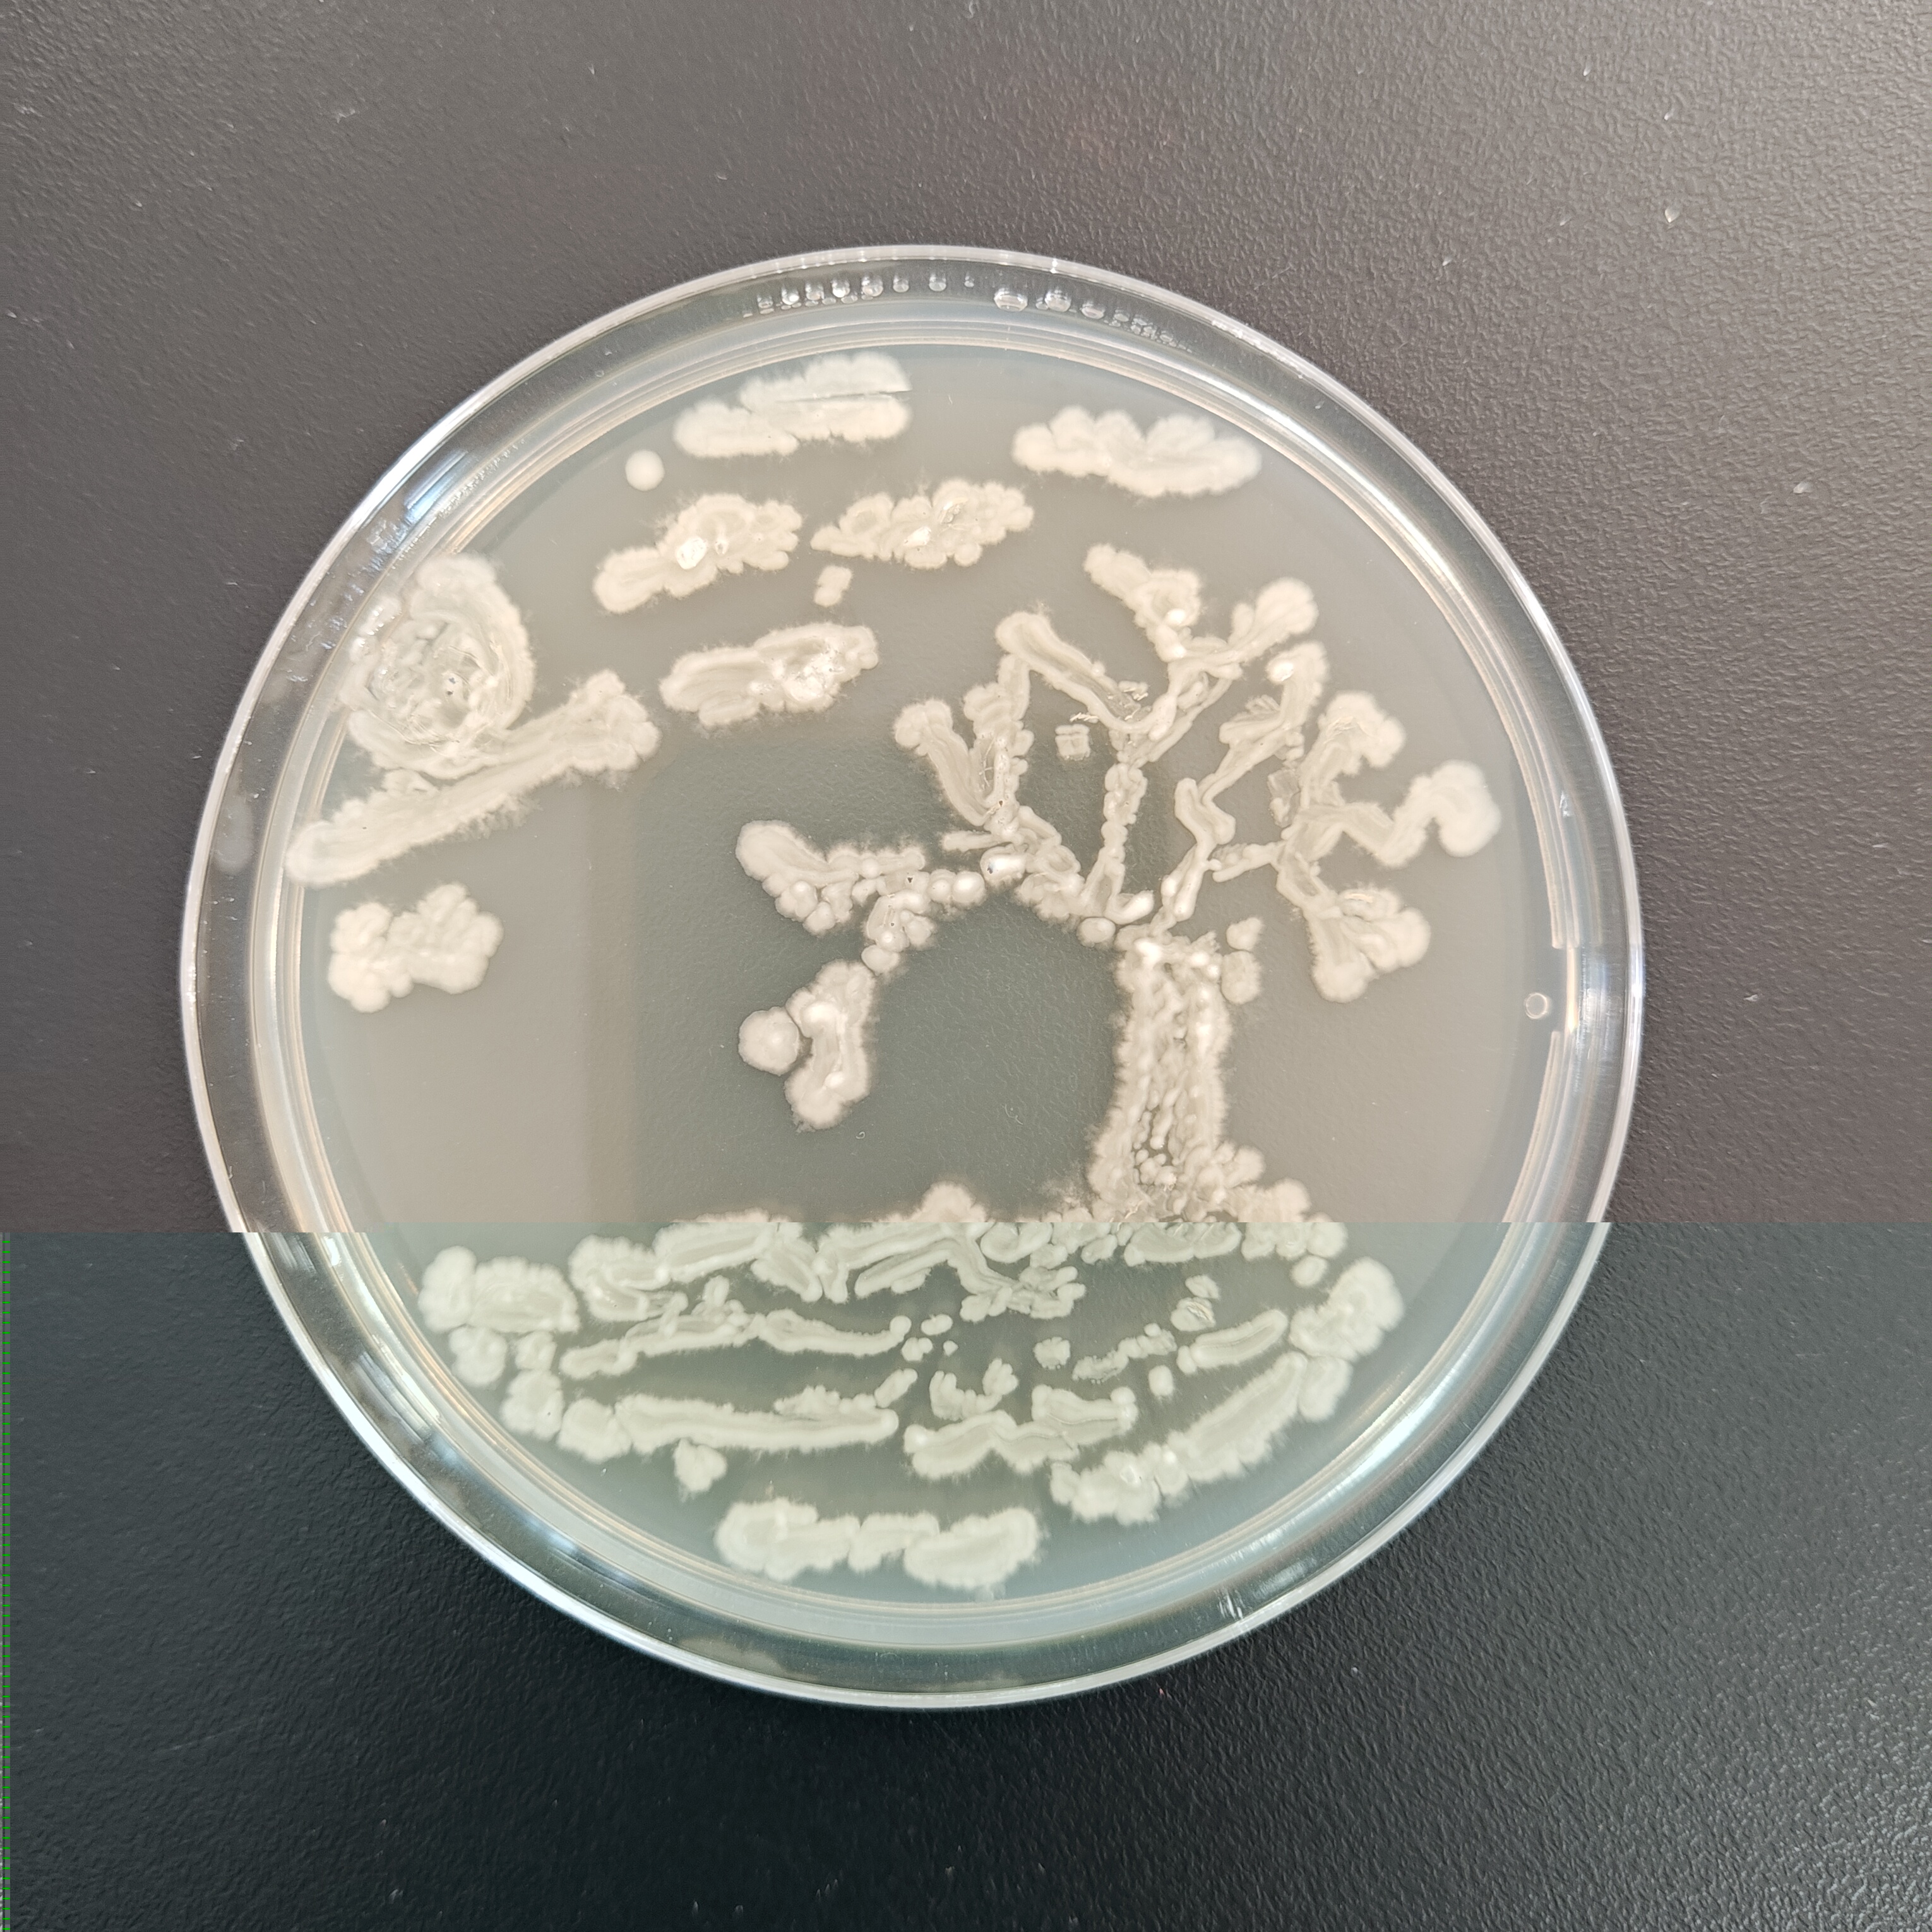
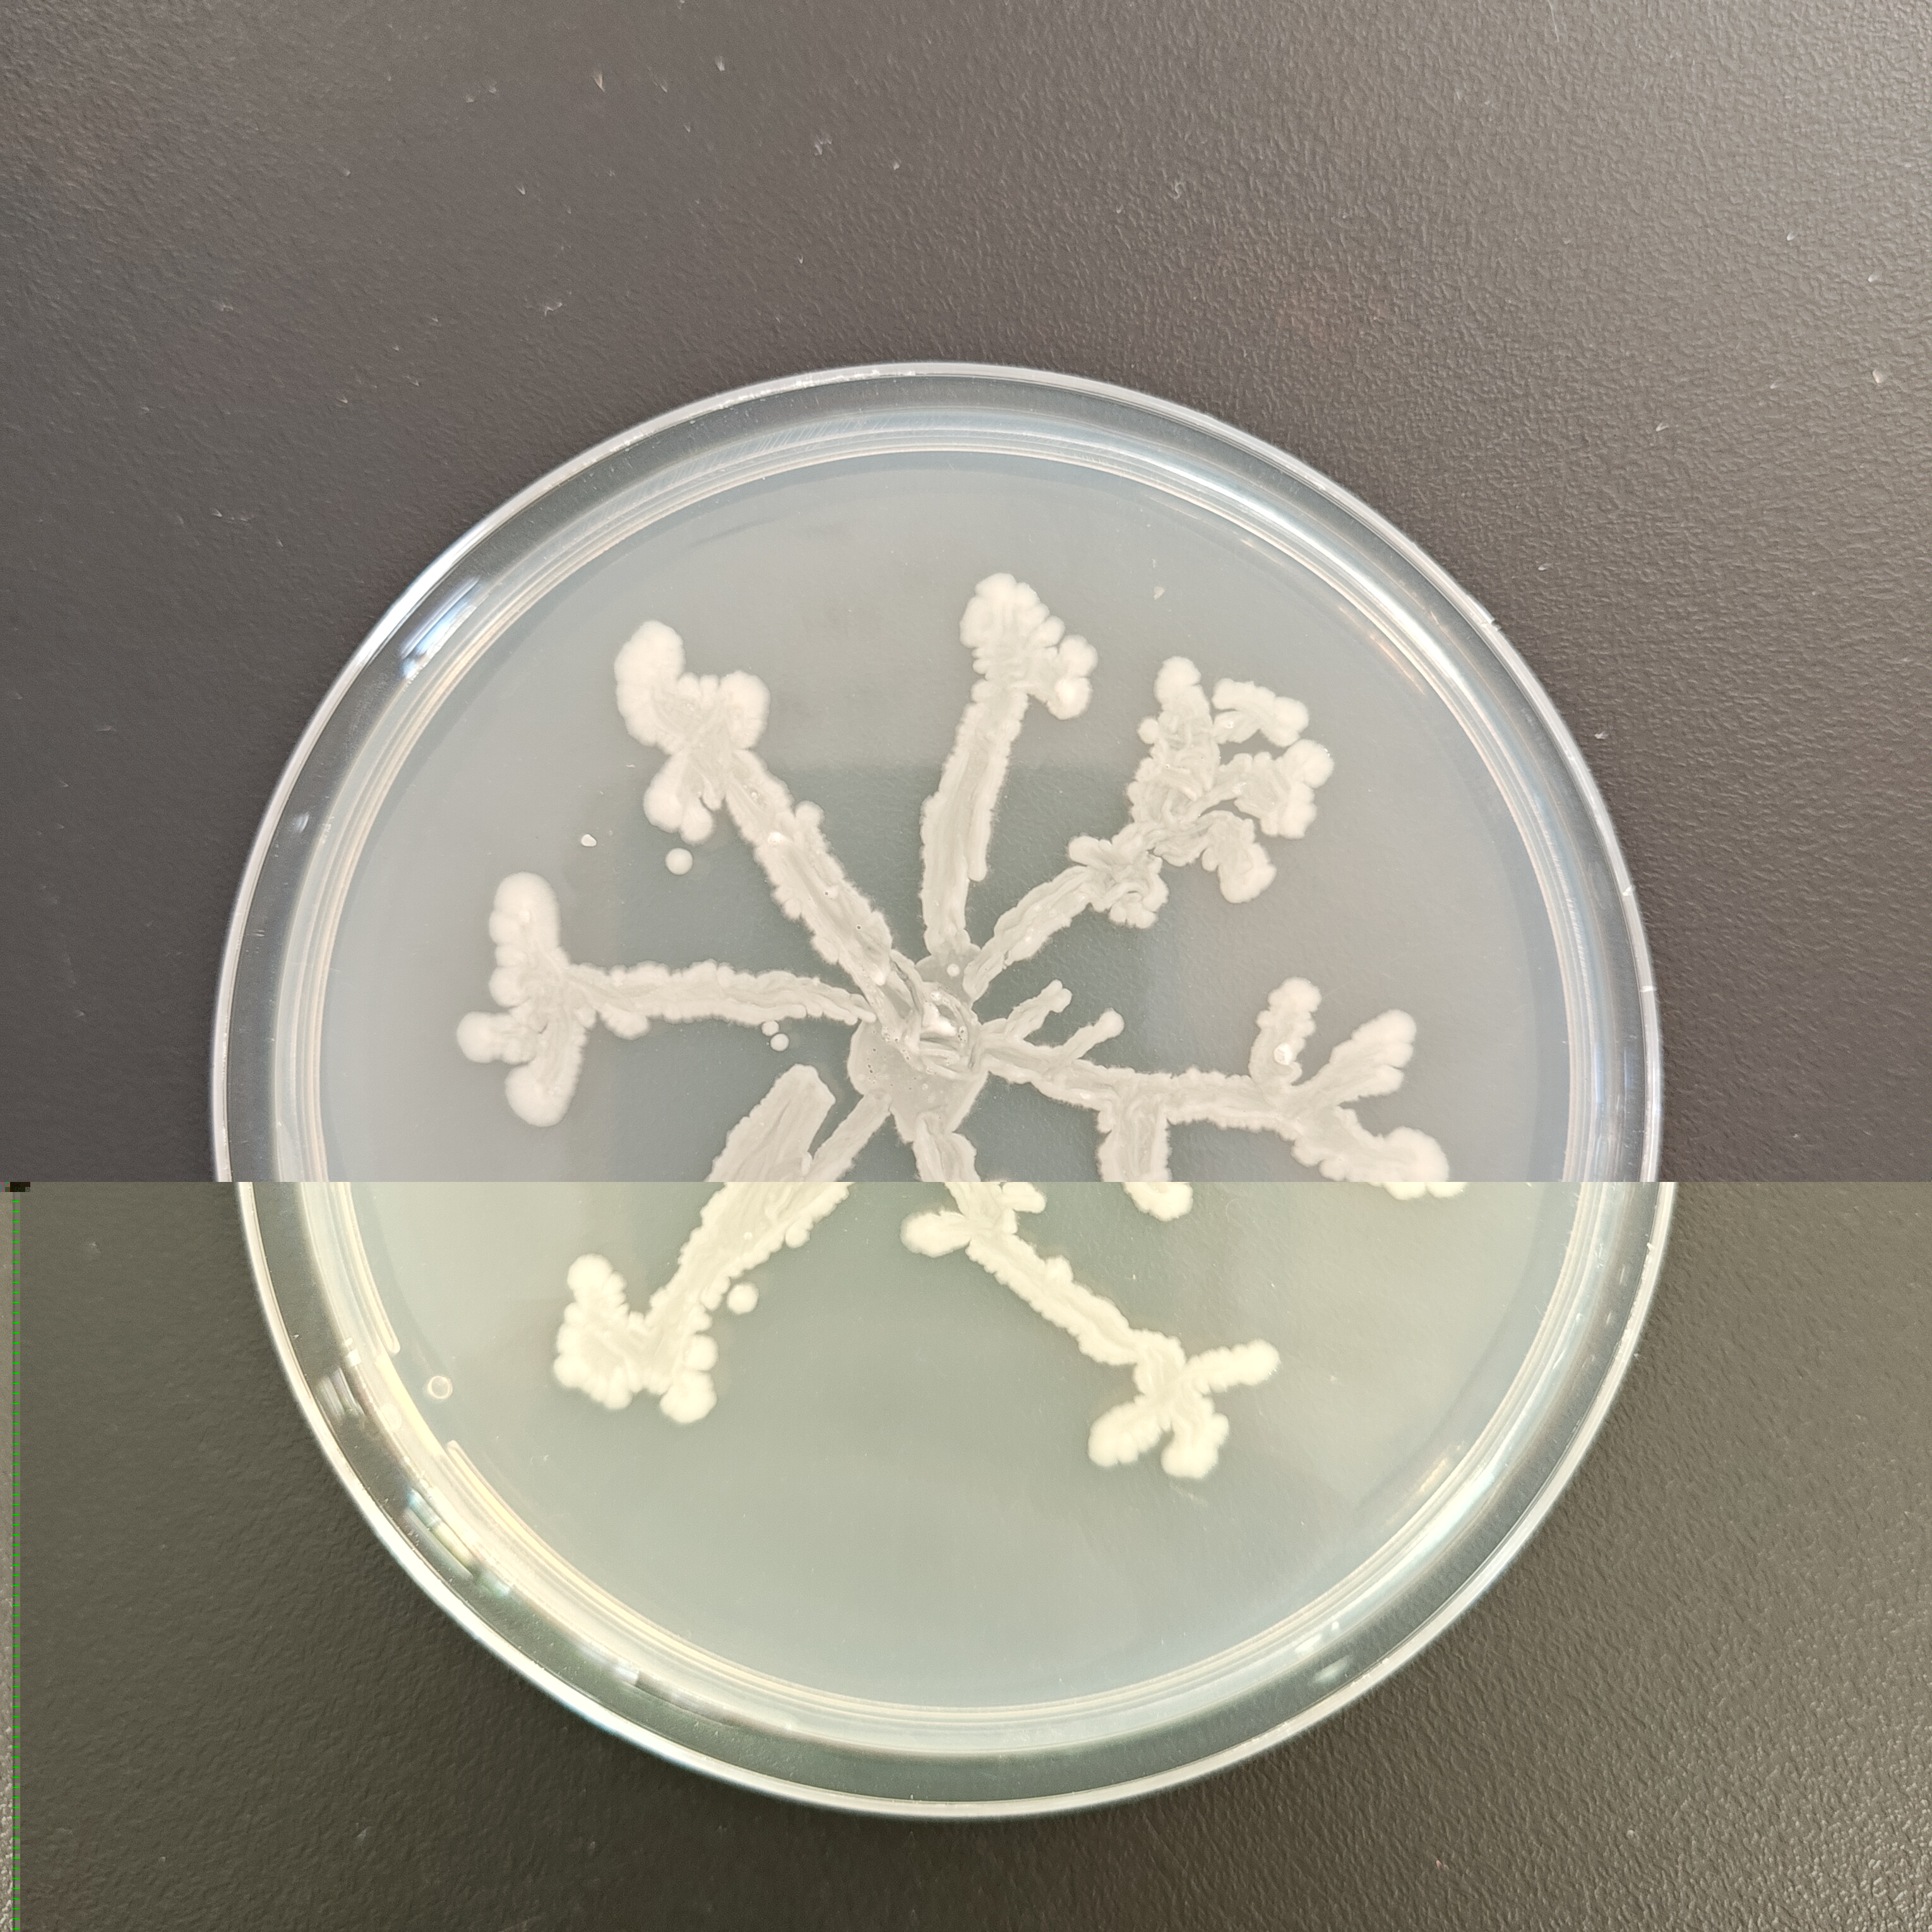
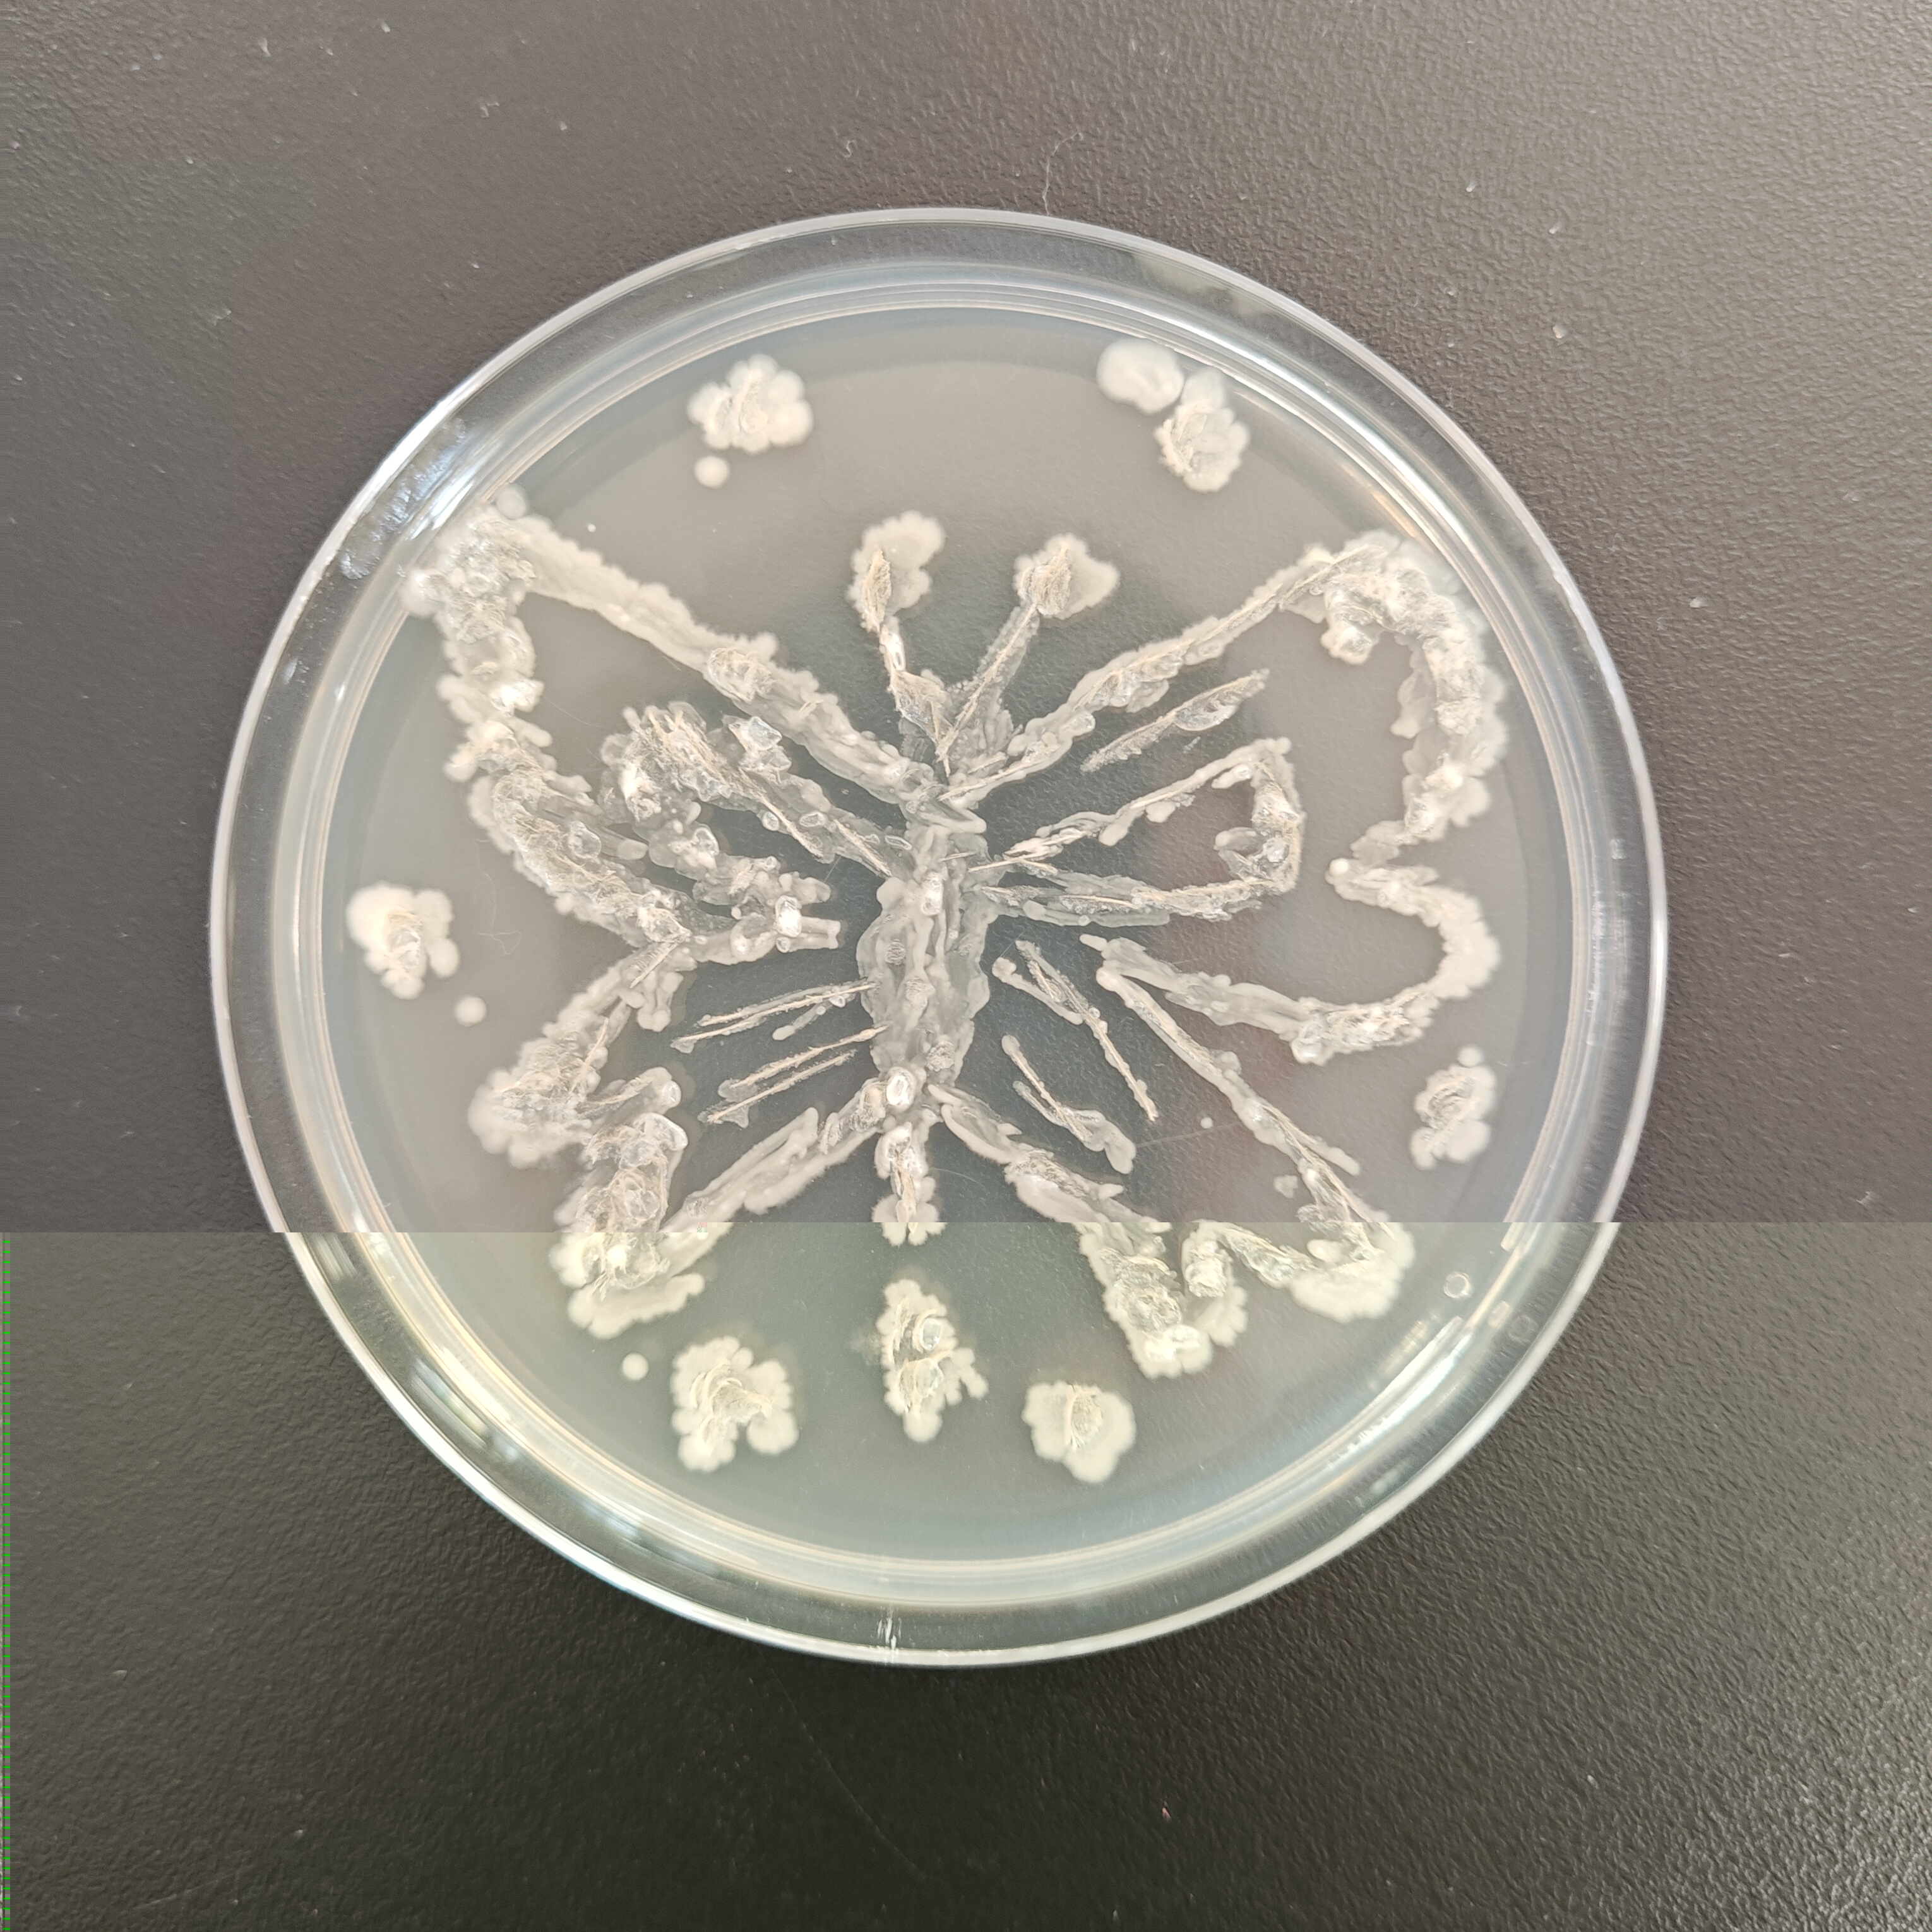
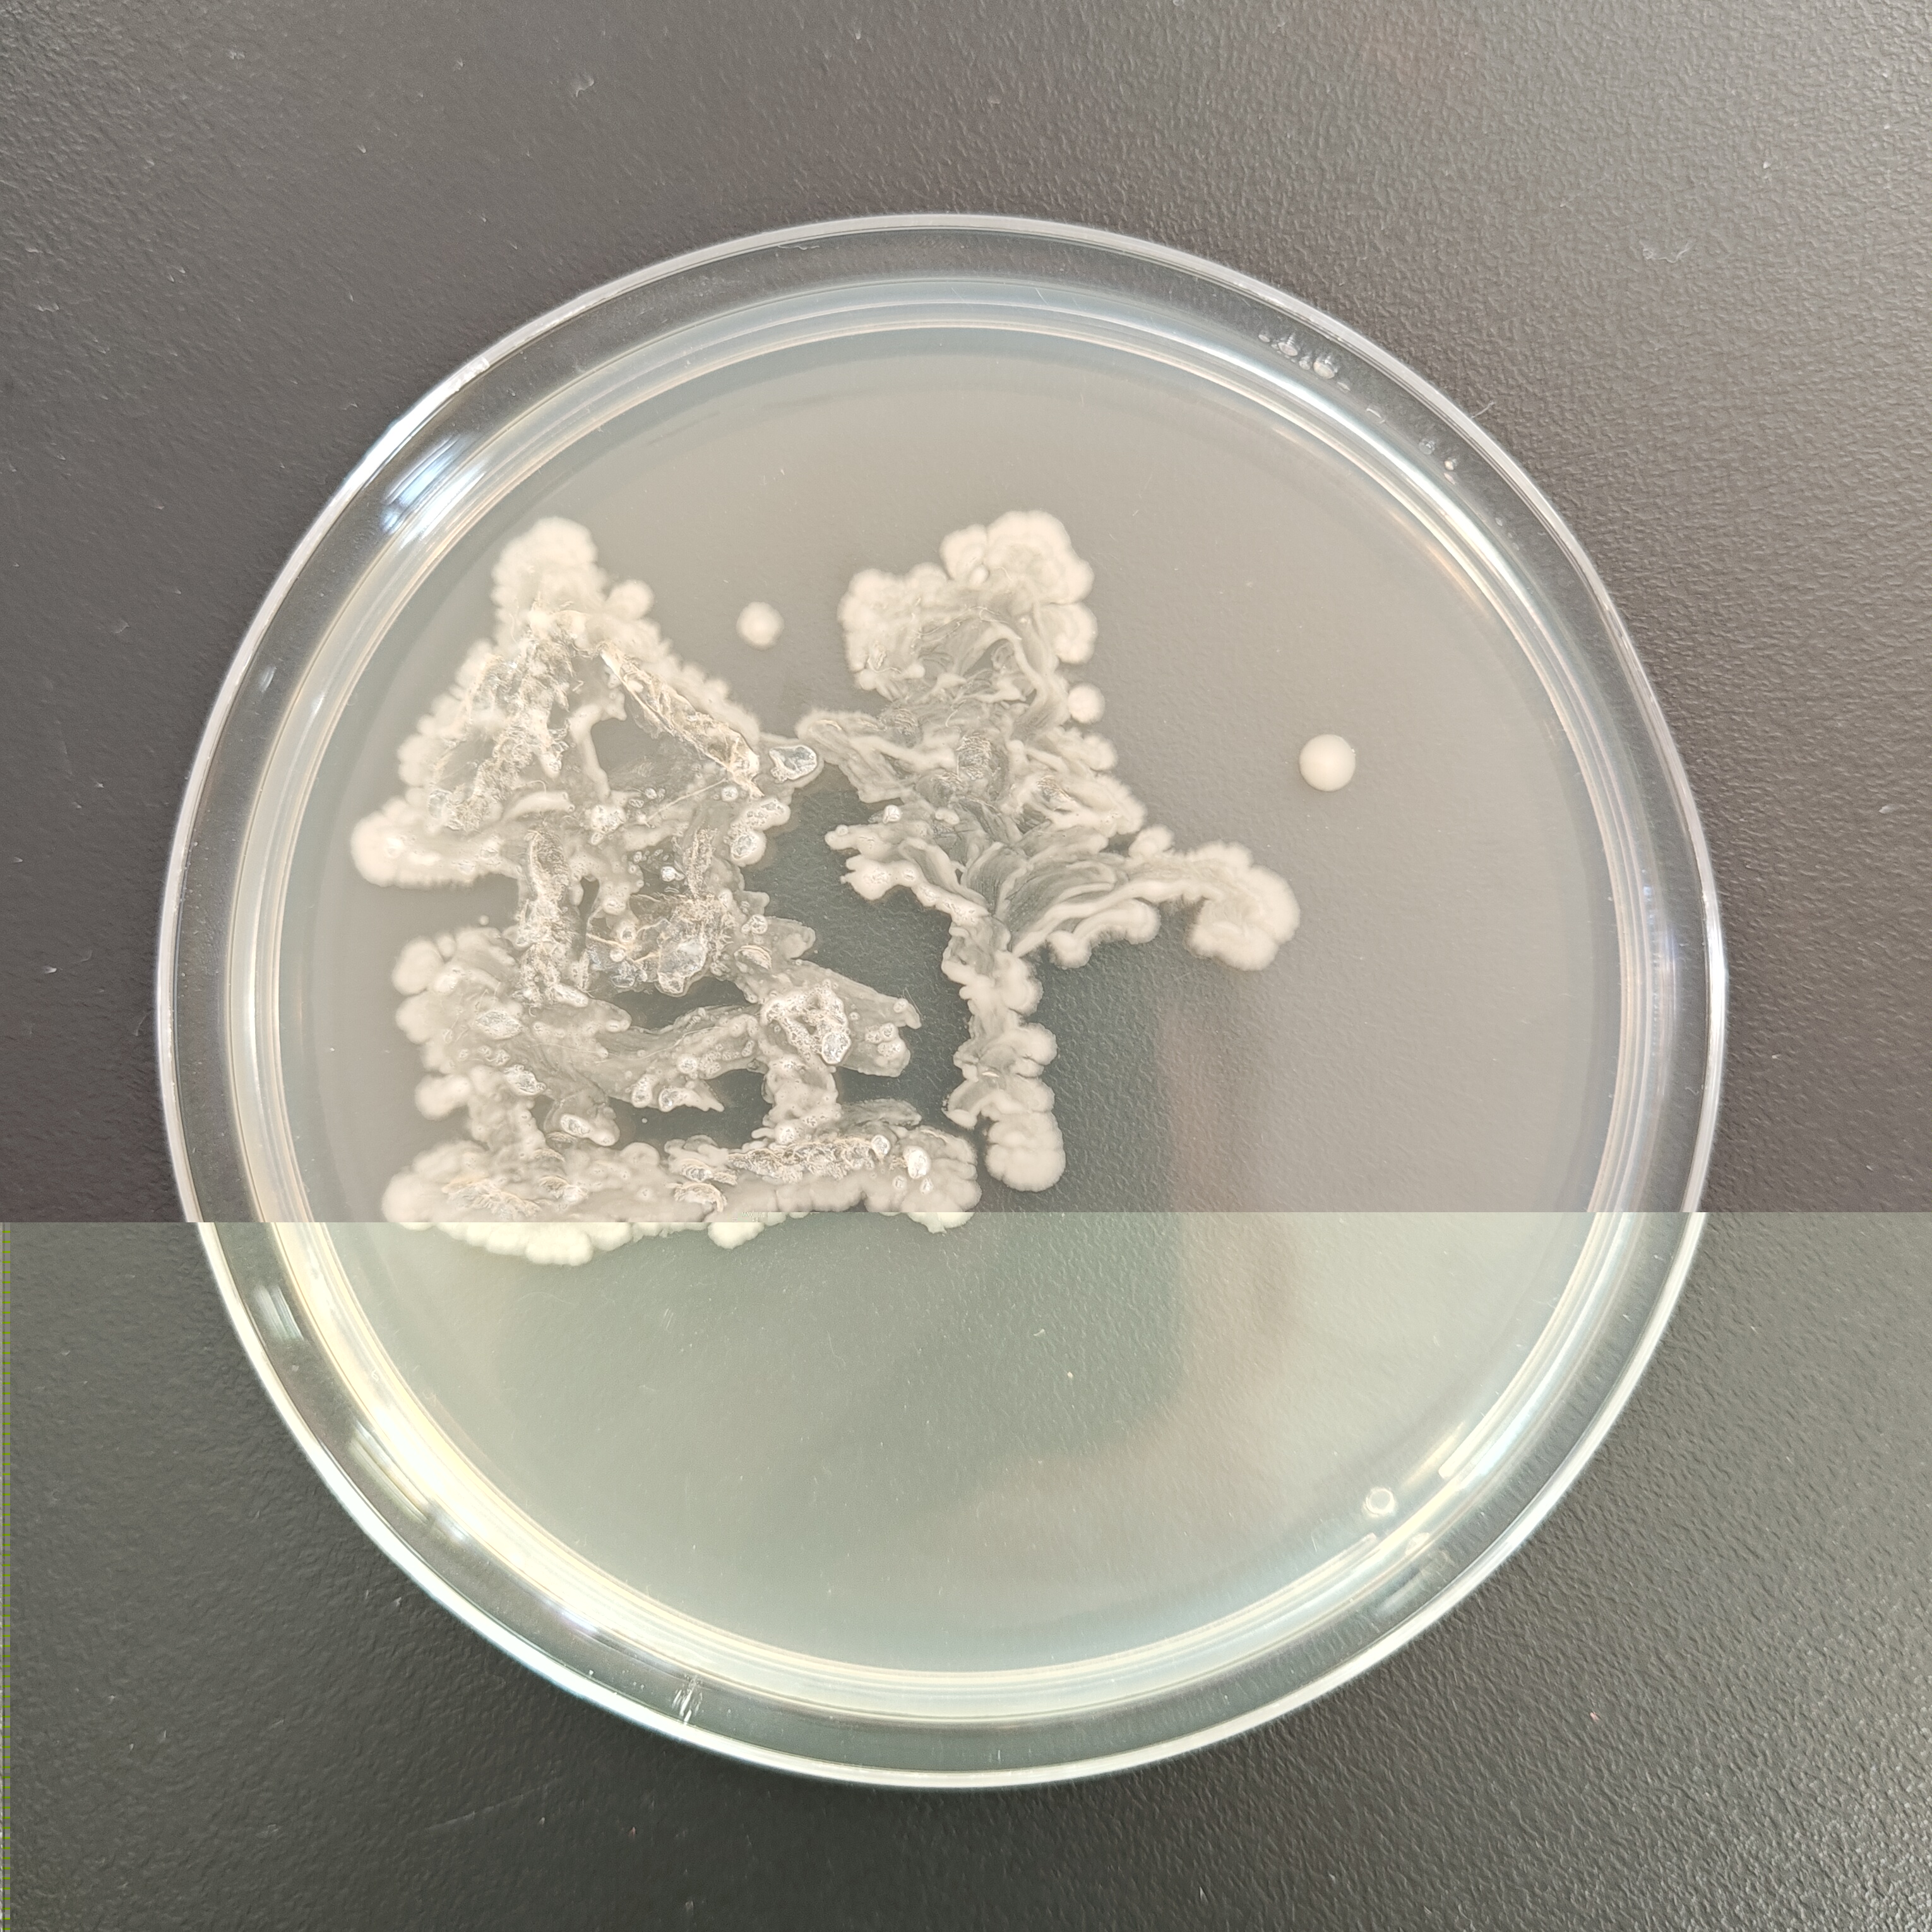
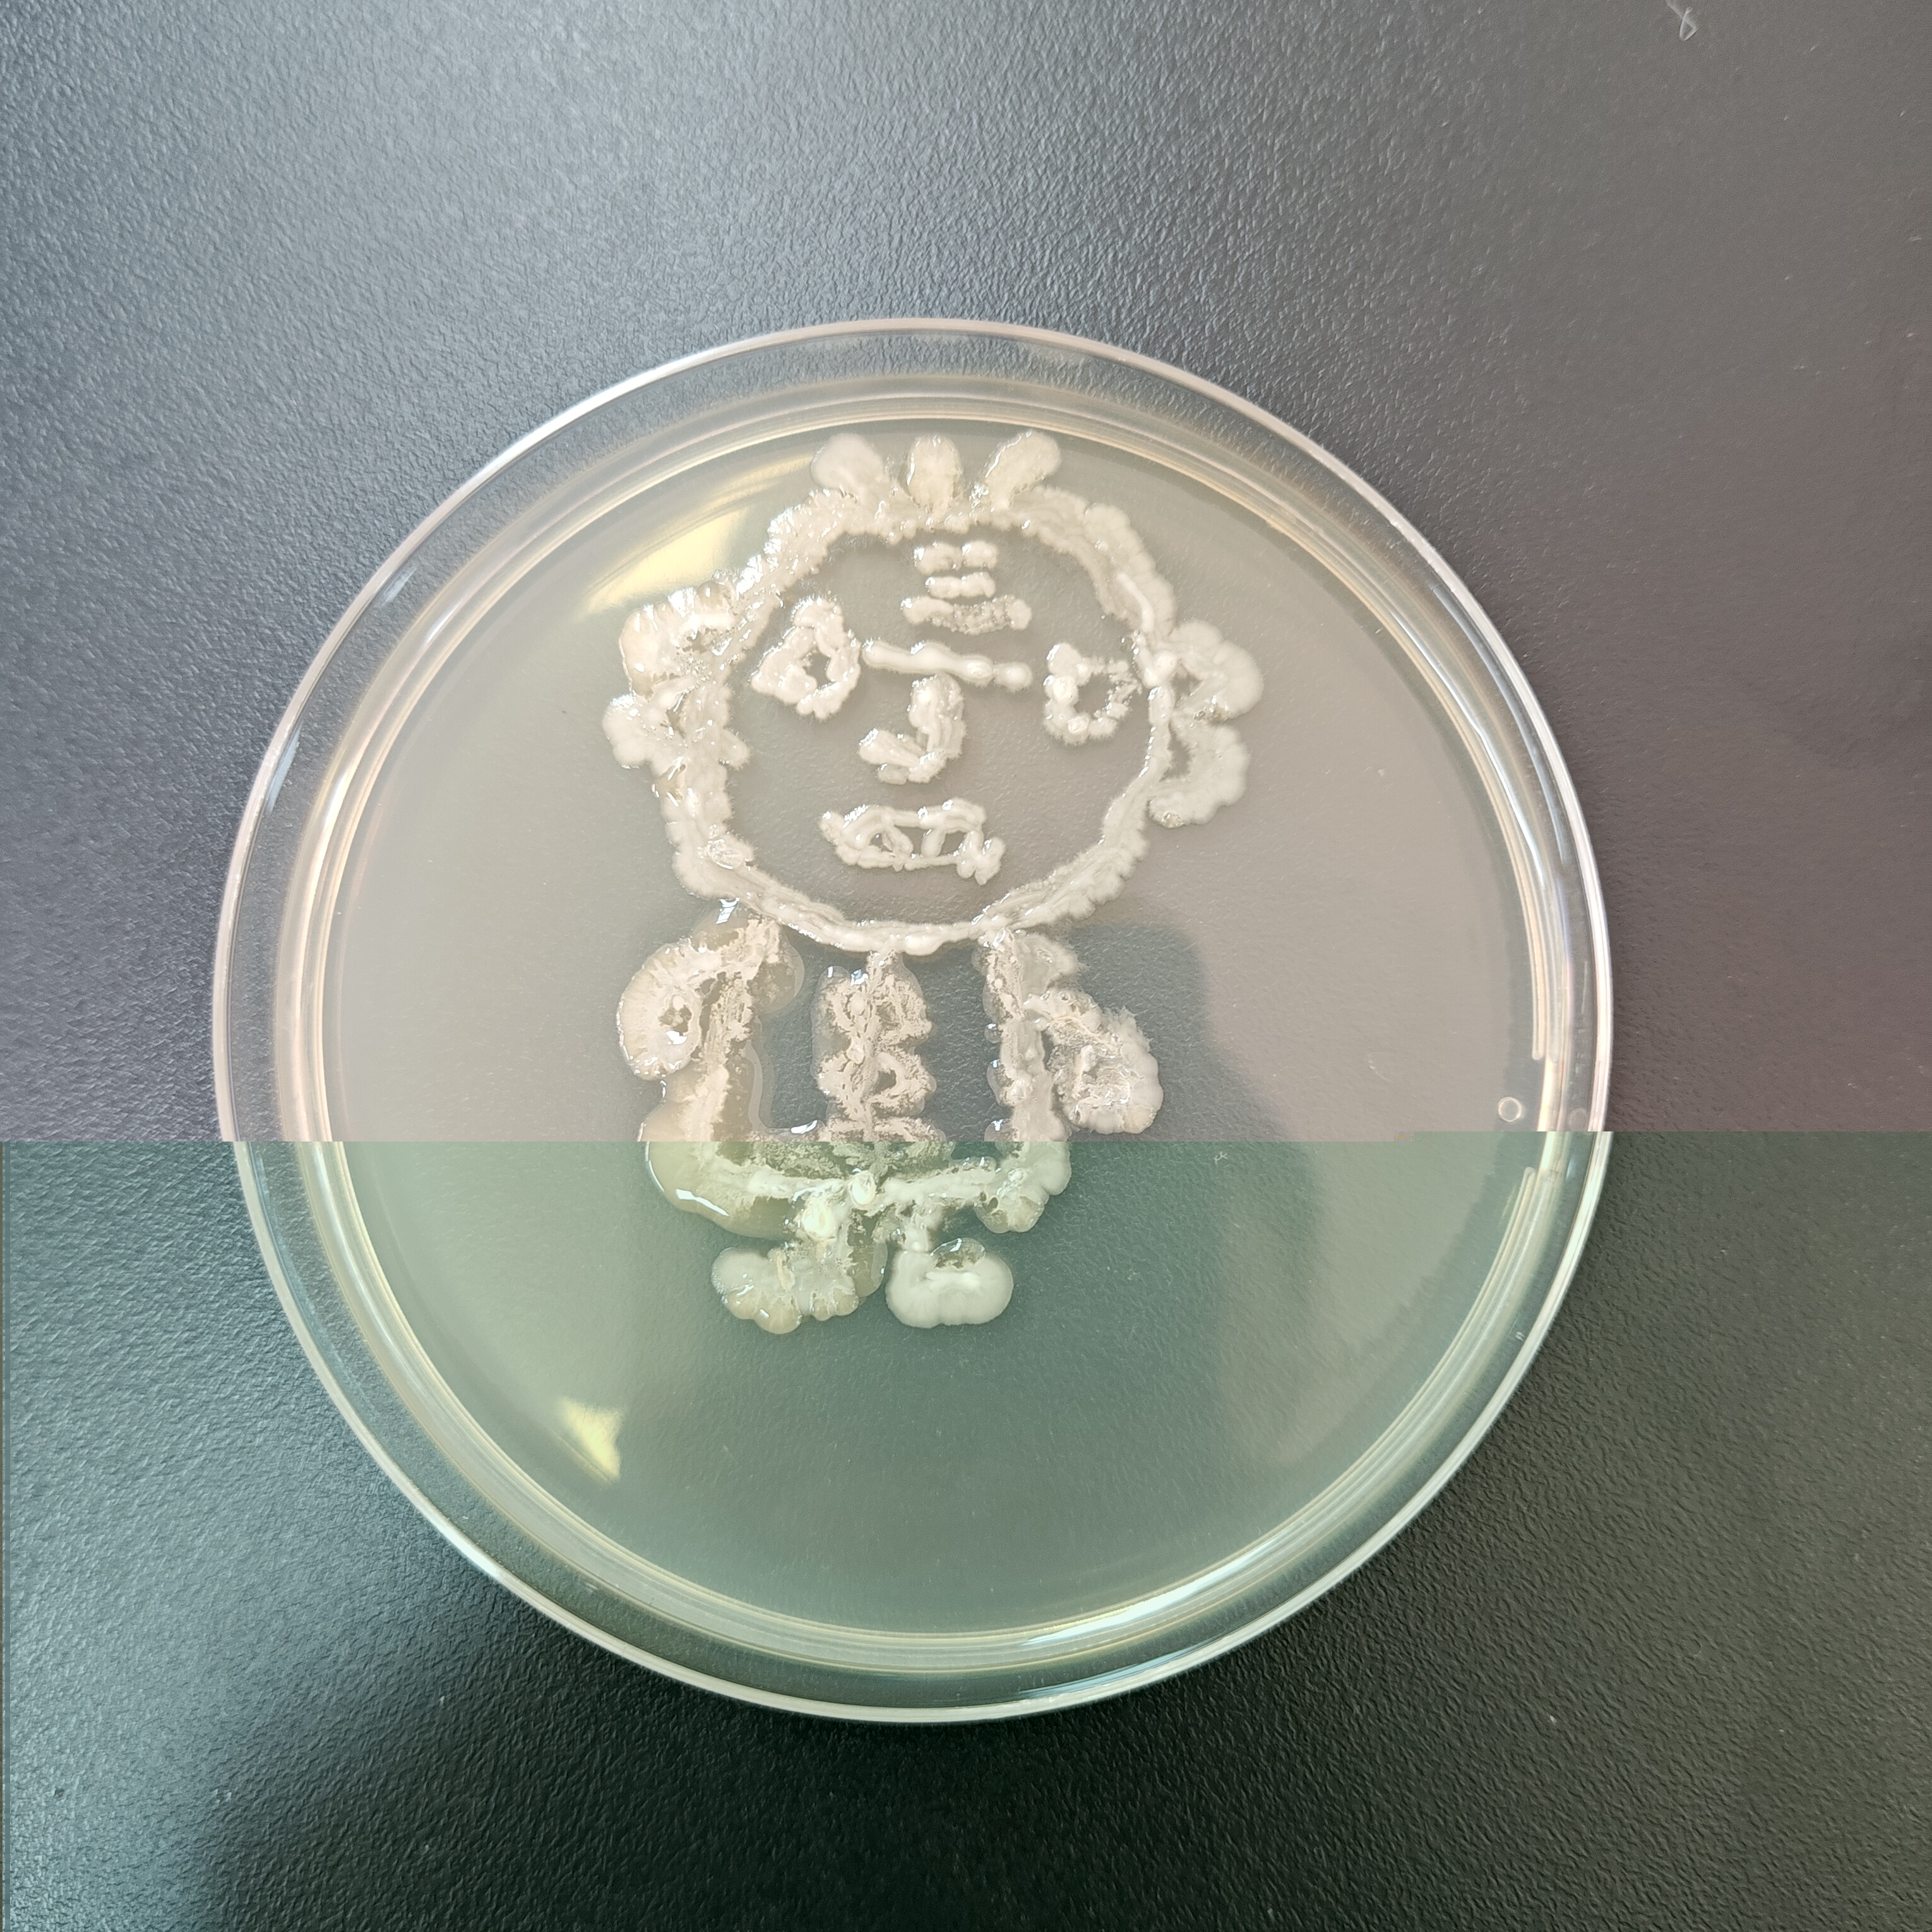

为培养学生的科学探究精神,锻炼实验能力,2024年12月18日至19日,海洋渔业学院在学院实验室举办了微生物创意比赛,本次比赛由新希望六和股份有限公司(华南大区)赞助,学院教师担任评委,2023级、2024级共54名同学参赛。
12月18日比赛当天,每3名同学组成一个小组,制作培养皿后,在超净工作台上进行操作。同学们以接种环作为“画笔”,挑取菌种——如乳酸菌、酵母菌等作为“颜料”,在培养皿上进行自由绘画创作。同学们凭借实验课积累的操作经验,自行掌握菌体的浓度,细致地勾勒出图案形态。绘画完毕,作品被放入恒温箱培养12个小时。次日,评委们通过观察作品长出的颜色及形态,并综合此前同学们的实验操作过程,依次对作品进行评分。
本次比赛评出一等奖2组,二等奖4组,三等奖6组。同学们在比赛中纷纷发挥了天马行空的想象力,创作出了一幅幅妙笔生花的作品。这些作品不仅展现了微生物的多样性和生命力,更体现了同学们对生物科学的热爱与追求!


部分参赛作品展示: